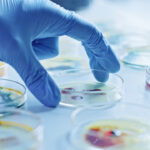
آزمایشگاه میکروبیولوژی عمومی – از صفر تا صد + بهترین منابع یادگیری

آزمایشگاه میکروبیولوژی عمومی – از صفر تا صد + بهترین منابع یادگیری
فعالیتهای صورت گرفته در آزمایشگاه میکروبیولوژی نقش مهمی در نظارت، درمان، کنترل و پیشگیری از عفونتهای بیمارستانی دارد. در آزمایشگاه میکروبیولوژی به کشت، بررسی و شناسایی میکروارگانیسمها از جمله باکتری، قارچ، مخمر و ویروس اختصاص دارد. آزمایشگاه میکروبیولوژی نقش مهمی در پیشگیری و کنترل موثر عفونت (IPC) دارد.

کاربرد آزمایشگاه میکروبیولوژی چیست؟
جداسازی و توصیف میکروارگانیسمهای عفونی که توسط آزمایشگاه میکروبیولوژی انجام میشود دو نقش مهم دارد:
- بالینی: مدیریت و درمان عفونت
- اپیدمیولوژیک: آگاهی از میکروب عفونی موجود در بیمار در بررسی منبع و نحوه انتقال آن
آزمایشگاه میکروبیولوژی توسط گروهی از متخصصان با صلاحیت و آموزش مناسب نظارت میشود. GMP متشکل از تکنیکهای آسپتیک و سایر تکنیکهای میکروبیولوژیک برای جلوگیری از آلودگی آزمایشگاه هنگام برخورد با میکروارگانیسمهای بسیار مهم است. GMP از تکنیکهای آزمایشگاهی میکروبیولوژیکی یا روشهای آزمایشگاهی میکروبیولوژی استفاده میکند تا میکروارگانیسمها را در محل امن خود بدون تماس با سایر موجودات زنده نگه دارد و همچنین ایمنی افراد اطراف را هنگام آزمایش در نظر داشته باشد.
سطوح ایمنی زیستی در آزمایشگاه میکروبیولوژی
سطوح ایمنی زیستی تعریفی جهت جلوگیری از خطر، حفظ سلامتی و ایمنی افراد مشغول در آزمایشگاه میکروبیولوژی و حفظ محیط زیست، در حین تحقیقات و فعالیتهای تشخیصی میکروارگانیسمها است. ایمنی زیستی یک مفهوم مهم در آزمایشگاه میکروبیولوژی محسوب میشود زیرا فعالیتهای تحقیقاتی شامل دستکاری سلولهای میکروبی، ممکن است بیماریزا باشند.
استفاده از تکنیکهای استاندارد میکروبیولوژیکی و امکانات مناسب برای سطح خطر مرتبط با گونههایی که کار بر روی آنها صورت میگیرد، به محافظت از محققان در برابر عفونتها در آزمایشگاه میکروبیولوژی و جلوگیری از انتقال آن کمک میکند.
بنابراین سطوح ایمنی زیستی برای شناسایی اقدامات حفاظتی مختلفی که باید در محیط آزمایشگاهی برای حفاظت از محققان، محیط زیست و میکروارگانیسمها انجام شود، طراحی شدهاند. این سطوح توسط مرکز کنترل و پیشگیری از بیماریها (CDC) تعریف و هریک از این سطوح با اقدامات خاص و الزامات ایمنی مشخص شدهاند. تعیین سطح ایمنی زیستی بر اساس ترکیبی از ویژگیهای طراحی، تجهیزات، شیوهها و روشهای مورد نیاز هنگام کار با عوامل گروههای مختلف خطر است.
تخصیص یک عامل بیماریزا به سطح ایمنی زیستی برای کارهای انجام شده در آزمایشگاه میکروبیولوژی باید بر اساس ارزیابی خطر باشد. ارزیابیهای تعیین سطح ایمنی زیستی مناسب، افراد در گروه خطر و سایر عوامل را در نظر میگیرند. بنابراین سطوح ایمنی زیستی ممکن است از منطقهای به منطقه دیگر متفاوت باشند. طبق CDC، سطوح ایمنی زیستی بر اساس خطر مرتبط با میکروارگانیسمها و امکانات موجود، چهار نوع هستند. سطوح مهار از سطح ایمنی زیستی 1 الی ۴ که پایینترین آن تا سطح 4 (BSL-4) متغیر است.

سطح ایمنی زیستی 1 چیست؟
سطح ایمنی زیستی 1 (BSL-1) سطح مناسب برای کار با عوامل میکروبی مشخص است که باعث ایجاد بیماری در افراد بالغ دارای ایمنی بالا نمیشوند و حداقل خطرات بالقوه را برای پرسنل آزمایشگاه و محیط ایجاد میکنند. ایمنی زیستی 1 پایینترین سطح ایمنی است و اقدامات احتیاطی مورد نیاز برای آن محدود و نه چندان گسترده هستند. این آزمایشگاهها فضای عمومی را فراهم میکنند که در آن با عوامل موثر که با بیماری در بزرگسالان سالم ارتباط ندارند، کار میشود.
آزمایشگاههای BSL-1 لزوماً از تردد عمومی ساختمان جدا نیستند. بیشتر کارها معمولاً بر روی بنچهای باز با استفاده از روشهای کلی میکروبیولوژیکی انجام میشود. طراحی منحصر به فرد آزمایشگاه یا تجهیزات مهار مورد نیاز نیست، اما بسته به ارزیابی خطر ممکن است مورد استفاده قرار گیرد. باید به پرسنل آزمایشگاه آموزشهای خاصی در مورد روشهایی که در آزمایشگاه انجام میشود داده شود، که تحت نظارت دانشمندی با آموزش میکروبیولوژی یا علوم مرتبط است. موارد زیر روشهای استاندارد، تجهیزات ایمنی و الزامات تاسیسات مورد نیاز در BSL-1 است:
- روشهای استاندارد میکروبیولوژیکی ناظر آزمایشگاه باید سیاستهای مربوط به کنترل دسترسی به آزمایشگاه را اجرا کند.
- پرسنل آزمایشگاه باید بعد از کار با مواد بالقوه خطرناک و قبل از خروج از آزمایشگاه، دستهای خود را بشویند.
- فعالیتهایی مانند خوردن، نوشیدن، سیگار کشیدن، استفاده از لنزهای تماسی، استفاده از لوازم آرایشی و نگهداری مواد غذایی در مناطق آزمایشگاهی مجاز نیست.
- استفاده از پیپت دهان ممنوع است.
- در تمام روشها از ایجاد اسپری و آئروسل جلوگیری شود.
- سطح کار بنچها باید بعد از کار و پس از ریختن مواد بیولوژیکی خطرناک ضد عفونی شود.
- کارشناس آزمایشگاه میکروبیولوژی باید اطمینان حاصل کند که تمام پرسنل آزمایشگاه هنگام انجام وظایف خود آموزشهای مناسب و اقدامات احتیاطی لازم را میبینند.
هیچ روش ایمنی خاصی برای BSL-1 مورد نیاز نیست. تجهیزات ایمنی برای BSL-1 نیازی به دستگاههای مهار ویژه مانند کابینتهای ایمنی زیستی نیستند. برای جلوگیری از آلودگی لباس شخصی، مانتو، روپوش یا لباس آزمایشگاهی محافظ توصیه میشود. هنگام انجام آزمایشات با احتمال زیاد تشکیل آئروسل، میتوان از عینک محافظ استفاده کرد. ایمنی زیستی سطح 1 معمولاً هنگام انجام آزمایش بر روی عوامل میکروبی که باعث ایجاد بیماری در افراد مبتلا به نقص ایمنی نمیشوند و در آزمایشگاههای آموزشی استفاده میشود.
ارگانیسمهای متداول که به حفاظت ایمنی زیستی سطح 1 احتیاج دارند شامل ارگانیسمهای کم خطر مانند لاکتوباسیلوس اسیدوفیلوس، رادیوباکتر آگروباکتریوم، آسپرژیلوس نیجر و سودوموناس هستند. با این حال، میزان ایمنی زیستی بسته به ارزیابی خطر پاتوژن ممکن است متفاوت باشد.

سطح ایمنی زیستی 2 چیست؟
آزمایشگاههایی با سطح ایمنی 2 (BSL-2) برای انجام وظایفی شامل کار عوامل میکروبی با خطرات احتمالی متوسط برای پرسنل آزمایشگاه، محیط و عامل مورد استفاده قرار میگیرند. با این حال، عوامل عفونی یا سموم ممکن است در صورت استنشاق، بلعیدن یا قرار گرفتن در معرض پوست خطر متوسطی را ایجاد کنند. اقدامات احتیاطی مربوط به ایمنی زیستی سطح 2 نسبتاً گستردهتر از BSL-1 است اما آزمایشگاههای BSL-1 و BSL-2 به طور کلی به عنوان آزمایشگاههای اساسی در نظر گرفته میشوند.
آزمایشگاههای BSL-2 مانند آزمایشگاههای BSL-1 لزوماً از الگوهای عمومی تردد در ساختمان جدا نیستند. با این حال، دسترسی به آزمایشگاه محدود است در حالی که آزمایش BSL-2 در حال انجام است. بازرسی سالانه آزمایشگاهها نیز بخش مهمی از الزامات BSL-2 است. این موارد ممکن است شامل تغییر فیلترها یا تعویض برخی دستگاهها باشد. این کار عمدتا بر روی بنچهای استریل انجام میشود به جز برخی از فرایندهایی که ممکن است آئروسل ایجاد کنند. دومی در کابینتهای ایمنی انجام میشود. اقدامات احتیاطی که باید در BSL-2 رعایت شود شامل کلیه اقدامات احتیاطی BSL-1 و برخی اقدامات احتیاطی اضافی است.
همه پرسنل آزمایشگاه باید بعد از استفاده از میکروارگانیسمهای زنده و قبل از خروج از آزمایشگاه دستهای خود را بشویند. خوردن، نوشیدن، سیگار کشیدن و استفاده از لنزهای تماسی در آزمایشگاه اکیداً ممنوع است. به جای پیپت دهان باید پیپت مکانیکی انجام شود. همه محیطکشتهای آلوده، ظروف شیشه ای، ظروف پلاستیکی و زبالههای آلوده بیولوژیکی باید به عنوان خطرات زیستی تلقی شوند و بنابراین اتوکلاو شوند. سطوح کار باید در انتهای روز یا بعد از هرگونه ریختن یا پاشیدن با مواد ضد عفونیکننده ضد عفونی شوند. سرنگها و سوزنهای زیر پوستی، پیپتهای پاستور، تیغها، شیشههای شکسته آلوده و ویالهای خون به عنوان زبالههای پزشکی تصفیه میشوند و در ظروف دفع تیز مقاوم در برابر سوراخ شدن دور ریخته میشوند.
افرادی که ریسک بالای ابتلا به عفونت دارند مانند مبتلایان به نقص ایمنی و افراد باردار، نباید.
وارد آزمایشگاههای BSL-2 شوند. برای به روزرسانی دستورالعملها، باید سالانه راهنمای BSL-2 را مرور کنید. فقط افرادی که آموزش صحیح کار در این آزمایشگاهها را دارند باید بتوانند وارد آن شوند. نماد خطر زیستی بر روی قطعاتی از تجهیزات که مواد زیستی خطرناک در آنها استفاده میشود یا ذخیره میشوند، قرار میگیرد.
هنگام ورود به آزمایشگاه، روپوش محافظ پوشیده میشود و هنگام خروج نیز باید در محل کار آزمایشگاه نگهداری شود. طراحی آزمایشگاه باید به گونهای باشد که بتوان به راحتی آن را تمیز و ضدعفونی کرد. هر زمان که کار با مواد زیستی خطرناک انجام میشود، درهای آزمایشگاه باید بسته شوند. اتوکلاو نیز باید در دسترس باشد. آزمایشگاههای سطح ایمنی 2 بیشتر برای تجزیه و تحلیل معمول و کشت عوامل خطرناک متوسط استفاده میشود. علاوه بر این، برخی از آزمایشگاههایی که برای اهداف آموزشی و تربیتی استفاده میشوند نیز آزمایشگاههای BSL-2 هستند.
ارگانیسمهایی که نیاز به آزمایشگاه BSL-2 دارند شامل سویههای بیماریزای اشرشیا کولی، ویروس هرپس سیمپلس، استافیلوکوکوس، سالمونلا، پلاسمودیوم فالسیپاروم و توکسوپلاسما
هستند.

سطح ایمنی زیستی ۳ چیست؟
در سطح ایمنی زیستی 3 (BSL-3) کار با عواملی انجام میشود که ممکن است از طریق استنشاق یا تشکیل آئروسل باعث ایجاد بیماری شدید یا بالقوه کشنده برای پرسنل شوند و محیط را آلوده کنند. وظایفی که در آزمایشگاههای BSL-3 انجام میشود شامل عوامل بومی یا عجیب است که احتمال عفونت توسط ذرات معلق در هوا زیاد است و این بیماری ممکن است پیامدهای کشندهای داشته باشد. تلقیح خودکار و بلعیدن، خطرات اولیه برای پرسنلی هستند که در این سطح با این عوامل کار میکنند. کار در چنین آزمایشگاهی مستلزم پرسنل آزمایشگاهی با آموزشهای خاص در زمینه برخورد با عوامل بیماریزا و بالقوه کشنده، همراه با دانشمندان ناظر در رسیدگی به عوامل عفونی و روشهای مرتبط است.
آزمایشگاههای مهار ایمنی زیستی سطح 3 برای حیوانات و تحقیقات، چالش برانگیزترین امکانات سطح مهار برای طراحی و راهاندازی است. این آزمایشگاهها باید برای استفاده قبل از عملیات اولیه و متعاقباً در برنامه سالانه یا پس از تغییر برنامه، نوسازی یا جایگزینی اجزای سیستم که ممکن است بر محیط کار آزمایشگاه تأثیر بگذارد، دارای مجوز باشند. آزمایشگاههای BSL-3 نیز آزمایشگاه مهار نامیده میشوند زیرا به تجهیزات مهار برای محافظت از پرسنل، عامل میکروبی و محیط نیاز دارند. الزامات BSL-3 شامل تمام الزامات آزمایشگاههای BSL-1 و BSL-2 به همراه برخی ویژگیهای طراحی اضافی و تجهیزات ویژه است.
ورود به آزمایشگاههای BSL-3 محدود به افرادی است که آموزشهای لازم را در زمینه رسیدگی به موجودات BSL-3 دارند که همه آنها توسط سرپرست آزمایشگاه انتخاب میشوند. علاوه بر رویههای عمومی و شیوههای آزمایشگاهی، ناظر همچنین سیاستهای اضافی برای محدود کردن ورود به آزمایشگاه تدوین میکند. تمام روشهایی که باید در BSL-3 انجام شود باید در داخل یک کابینت ایمنی زیستی انجام شود تا از قرار گرفتن در معرض آئروسلها در برابر پرسنل آزمایشگاه جلوگیری شود.
پرسنلی که در آزمایشگاه کار میکنند باید قبل از ورود به آزمایشگاه از تجهیزات حفاظتی شخصی استفاده کرده و سپس قبل از خروج آنها را بردارند. سطوح کار و سینکها باید یکبار در هر نوبت کاری یا بعد از هرگونه ریختن یا پاشیدن، ضدعفونی شوند. آزمایشگاههای BSL-3 باید از تردد عمومی در یک ساختمان جدا شوند تا ورود به آزمایشگاهها در هر زمان محدود شود.
درهای آزمایشگاههای BSL-3 با علائم مناسب BSL-3 در خارج از مجموعه، همراه با علامت جهانی خطر زیستی و اطلاعات تماس اضطراری، همیشه بسته است. پرسنل آزمایشگاه باید نظارت پزشکی داشته باشند و واکسیناسیون مناسب را برای عوامل دستکاری شده یا بالقوه موجود در آزمایشگاه ارائه دهند. هر مؤسسه باید به جمعآوری و ذخیره نمونههای سرم از پرسنل در معرض خطر توجه کند. یک دفترچه راهنمای ایمنی زیستی مخصوص آزمایشگاه، که در دسترس و در دسترس همگان است، باید تهیه و به عنوان یک سیاست اتخاذ شود.
کارشناس آزمایشگاه میکروبیولوژی باید قبل از کار با عوامل BSL-3، مهارت همه روشهای استاندارد و ویژه میکروبیولوژیکی را توسط تمام پرسنل آزمایشگاه بررسی کند. مواد بالقوه خطرناک باید در ظرف جمع آوری، پردازش، ذخیرهسازی یا حمل و نقل در یک مرکز در یک ظرف یا ویال مقاوم و ضد نشت قرار داده شوند. کلیه تجهیزات آزمایشگاهی باید به طور معمول پس از کار یا پس از هرگونه ریختن یا پاشیدن، ضد عفونی شوند.

دفترچه راهنمای ایمنی زیستی آزمایشگاه باید روشهایی را که در صورت قرار گرفتن در معرض مواد عفونی اتخاذ میشود، مشخص کند و باید طبق آن رفتار شود. هیچ کار در آزمایشگاههای BSL-3 نباید روی نیمکت باز یا کشتی باز انجام شود. کلیه فعالیتهای مربوط به عوامل عفونی باید در کابینتهای ایمنی زیستی یا سایر وسایل مهار فیزیکی انجام شود. ورود به آزمایشگاههای BSL-3 محدود به افرادی است که آموزشهای لازم را در زمینه رسیدگی به موجودات BSL-3 دارند که همه آنها توسط سرپرست آزمایشگاه انتخاب میشوند.
علاوه بر رویههای عمومی و شیوههای آزمایشگاهی، ناظر همچنین سیاستهایی برای محدود کردن ورود به آزمایشگاه تدوین میکند. تمام روشهایی که باید در BSL-3 انجام شود باید در داخل یک کابینت ایمنی زیستی انجام شود تا از قرار گرفتن در معرض آئروسلها در برابر پرسنل آزمایشگاه جلوگیری شود. سطوح کار و سینکها باید یک بار در هر نوبت کاری یا بعد از هرگونه استفاده، ضدعفونی شوند. آزمایشگاههای BSL-3 باید از تردد عمومی در یک ساختمان جدا شوند تا ورود به آزمایشگاهها در هر زمان محدود شود.
در آزمایشگاههای BSL-3 نباید روی بنچ باز کار انجام شود. کلیه فعالیتهای مربوط به عوامل عفونی باید در کابینتهای ایمنی زیستی یا سایر وسایل مهار فیزیکی انجام شود. از کابینتهای ایمنی زیستی برای دستکاری همه عوامل عفونی استفاده میشود. وسایل حفاظتی فردی مانند تجهیزات حفاظتی شخصی، روپوش، دستکش و محافظ تنفسی باید هنگام ورود به آزمایشگاه پوشیده و قبل از خروج برداشته شوند. هوایی که در آزمایشگاه جریان دارد نباید در هیچ قسمتی از آزمایشگاه چرخش مجدد داشته باشد و قبل از تخلیه به بیرون با فیلتر HEPA فیلتر شود. فیلترها، کتابچههای راهنما، تجهیزات، لولههای خلأ، اتوکلاوها و غیره باید سالانه مورد بازبینی و بررسی قرار بگیرند.
BSL-3 برای کار بالینی، تشخیصی، آموزشی، تحقیقاتی یا تولیدی استفاده میشود. این آزمایشگاهها برای دستکاری عوامل بسیار عفونی و مطالعات مربوط به تأثیر عوامل عفونی و سموم مختلف و اثرات آنها استفاده میشود. از عوامل بیماریزایی که نیاز به آزمایشگاه BSL-3 دارند میتوان به HIV، آنفولانزای H1N1، مایکوباکتریوم توبرکلوزیس (سل)، سارس (SARS)، ویروس هاری، ویروس نیل غربی و راشیتس اشاره کرد. با این حال قرار دادن ارگانیسمها در سطوح مختلف ایمنی زیستی ممکن است به تعویق بیفتد و همچنین باید پس از ارزیابی خطر تعیین شود.
سطح ایمنی زیستی 4 چیست؟
سطح ایمنی زیستی 4 بالاترین سطحی است که هنگام کار با عوامل عفونی خطرناک استفاده میشود که خطرات فردی و محیطی بالایی را در قالب بیماریهای تهدید کننده زندگی، انتقال آئروسل یا خطر ناشناخته انتقال نشان میدهد. آزمایشگاههای BSL-4 اغلب هنگام دستکاری و دستکاری عوامل بیماریزای گروه خطر که بسیار خطرناک هستند، بدون واکسن یا درمان شناخته شده، استفاده میشوند و احتیاطهای شدید در حین کار نیاز دارند. آزمایشگاههای BSL-4 دو نوع هستند. آزمایشگاه کابینت که در آن کلیه کارها در یک کابینت ایمنی ایمنی کلاس III یا محفظه فیزیکی مشابه با احتیاطات بسیار دقیق و آزمایشگاه مناسب انجام میشود که در آن کلیه پرسنل آزمایشگاه ملزم به پوشیدن چرخ دنده های محافظ کامل بدن و تامین هوا به شکل وسایل حفاظتی هستند.
الزامات آزمایشگاههای BSL-4 با طراحی آزمایشگاهی خاص، روش های آموزشی و تجهیزات بسیار محافظ و چرخ دنده های شخصی بسیار گسترده است. این آزمایشگاهها باید برای استفاده قبل از عملیات اولیه و متعاقباً در برنامه سالانه یا پس از تغییر برنامه، نوسازی یا جایگزینی اجزای سیستم که ممکن است بر محیط کار آزمایشگاه تأثیر بگذارد، دارای مجوز باشند. آزمایشگاههای BSL-4 همچنین آزمایشگاههای حداکثر مهار نامیده میشوند زیرا دارای موانع ثانویه برای جلوگیری از نفوذ مواد خطرناک به محیط هستند. آزمایشگاههای BSL-4 باید الزامات همه BSL-1، BSL-2 و BSL-3 را همراه با اقدامات احتیاطی خاص دیگر رعایت کنند.
هیچ کار انجام شده در BSL-4 نباید روی نیمکت باز یا کشتی باز انجام شود. ایستگاه های کار، تجهیزات و سینک ها باید بعد از کار استریل شوند. پرسنل آزمایشگاه باید وسایل محافظتی داشته باشند که ممکن است شامل PPP های کامل بدن، دستکش، ماسک و کت باشد. درهای آزمایشگاهها باید همیشه بسته باشند و آزمایشگاه دور از تردد عمومی ساختمان قرار گیرد. از فعالیتهایی مانند نوشیدن، غذا خوردن، پیپ زدن دهان باید به هر قیمتی اجتناب شود. فقط افرادی که در کار با موجودات BSL-4 و تجهیزات آزمایشگاهی آموزش دیدهاند باید به آزمایشگاه اجازه داده شوند.
مواد بیولوژیکی زنده یا دست نخورده که از کابینت کلاس III در BSL-4 خارج میشوند، در یک ظرف اصلی نشکن و نشکن با یک ظرف ثانویه نشکن و مهر شده منتقل میشوند. هیچ مادهای، بجز مواد بیولوژیکی که باید در وضعیت قابل دوام یا دست نخورده باقی بمانند، از آزمایشگاه BSL-4 خارج نمیشوند مگر اینکه قبل از خروج از تاسیسات اتوکلاو یا ضدعفونی شده باشند. فقط افرادی که حضور آنها در تأسیسات برای فرآیندهای میکروبیولوژیکی یا اهداف پشتیبانی مورد نیاز است مجاز به ورود هستند.
افرادی که در معرض خطر ابتلا به عفونت هستند یا ممکن است عفونت برای آنها خطرناک باشد، در آزمایشگاه مجاز نیستند. پرسنل فقط پس از تعویض لباس و از طریق دوش حمام می توانند وارد محل شده و از آن خارج شوند. هنگامی که آزمایشگاه BSL-4 در حال کار است یا هنگامی که مواد عفونی یا حیوانات آلوده در آزمایشگاه وجود دارد، یک علامت هشداردهنده خطر به همراه نماد جهانی خطر زیستی روی همه درهای دسترسی قرار میگیرد. سیستمی برای گزارش حوادث آزمایشگاهی، مواجهه و نظارت پزشکی بر بیماریهای احتمالی مرتبط با آزمایشگاه ایجاد شده است.
آزمایشگاههای BSL-4 برای کارهای تشخیصی و تحقیقاتی در مورد عوامل بیماریزا به راحتی منتقل و باعث بیماریهای کشنده میشوند. این آزمایشگاهها برای میکروبهای بیماریزای جدید و ناشناخته مورد استفاده قرار میگیرند که هیچ واکسن یا درمانی برای آنها در دسترس نیست. آنها همچنین برای امکانات بالینی و تولیدی که نیاز به تکنیکهای بسیار پیچیده و فرایندهای پیشرفته دارند استفاده میشوند. عوامل بیماریزای سطح BSL-4 شامل ارگانیسمهای گروه IV مانند ویروس ابولا، SARS-CoV-2، ویروس انسفالیت اروپای مرکزی، ویروسهای هموراژیک و غیره هستند.

تکنیکهای آزمایشگاه میکروبیولوژی چه هستند؟
تکنیک آسپتیک در آمادهسازی و تجزیه و تحلیل آزمایشگاه تکنیک آسپتیک روشی است که در شرایط استریل انجام میشود تا از ورود موجودات ناخواسته یا آلودگیهای باکتریایی به محیط جلوگیری شود. این یک روش آزمایشگاهی میکروبیولوژیکی مهم برای جلوگیری از هرگونه آلودگی پرسنل، محیط کشتها و تجهیزات آزمایشگاهی است.
استرلیزاسیون (Sterilization) فرآیند آلودگیزدایی است که در آن تمام اشکال میکروارگانیسمها و اسپورهای آنها (به عنوان مثال باکتریها، ویروسها، پریونها) در سطح، شی یا مایع، به عنوان مثال مواد غذایی یا محیط کشت بیولوژیک از بین میروند. این معمولاً از طریق روشهای فیزیکی مانند گرما، تابش و فیلتراسیون یا با روشهای شیمیایی انجام میشود. می توان استرلیزاسیون را از طریق روش های مختلف از جمله گرما، مواد شیمیایی، تابش، فشار بالا و فیلتراسیون انجام داد.
استرلیزاسیون از گندزدایی، ضدعفونی و پاستوریزاسیون متمایز است، زیرا این روشها به جای از بین بردن همه اشکال زندگی و عوامل بیولوژیکی موجود، باعث کاهش آنها میشود. پس از استرلیزاسیون، یک جسم استریل یا آسپتیک نامیده میشود. یکی از اولین گامها در جهت استرلیزاسیون مدرن توسط نیکلاس آپرت انجام شد که کشف کرد که استفاده کامل از گرما در یک دوره مناسب، پوسیدگی مواد غذایی و مایعات مختلف را کند کرده و آنها را برای مدت طولانیتری نسبت به حالت عادی حفظ میکند.
کنسرو کردن مواد غذایی همان اصل است و به کاهش بیماریهای منتقله از غذا (مسمومیت غذایی) کمک کرده است. سایر روشهای استرلیزاسیون مواد غذایی شامل تابش غذا و فشار بالا (پاسکالیزاسیون) است. یکی از فرایندهای استریل کردن غذا، عملیات حرارتی است. عملیات حرارتی فعالیت باکتریایی و آنزیمی را متوقف میکند که در نتیجه منجر به کاهش شانس غذاهای با کیفیت پایین میشود و در عین حال عمر غذاهای غیرقابل فساد را حفظ میکند. یک نوع خاص از عملیات حرارتی مورد استفاده استریلیزاسیون UHT (دمای فوق العاده بالا) است.
این نوع عملیات حرارتی بر ضدعفونی بیش از 100 درجه سانتیگراد متمرکز است. دو نوع استریلیزاسیون UHT استرلیزاسیون با حرارت مرطوب و خشک است. در حین استرلیزاسیون با حرارت مرطوب، دمای مورد استفاده از 110 تا 130 درجه سانتیگراد متغیر است. استریلیزاسیون با گرمای مرطوب بین 20 تا 40 دقیقه طول میکشد، اما هرچه درجه حرارت بالاتر باشد، زمان کوتاهتر میشود. استفاده از استریلیزاسیون با حرارت خشک از زمانهای حساسیت بیشتری استفاده میکند که ممکن است تا 2 ساعت طول بکشد و در مقایسه با استرلیزاسیون با حرارت مرطوب از دمای بسیار بالاتری استفاده میکند. این درجه حرارت ممکن است از 160 تا 180 درجه سانتیگراد متغیر باشد.

هدف از استرلیزاسیون کاهش میکروارگانیسمهای اولیه یا سایر عوامل بیماریزای بالقوه است. درجه استرلیزاسیون معمولاً با مضاعف زمان کاهش اعشاری یا مقدار D بیان می شود و زمان مورد نیاز برای کاهش عدد اولیه به یک دهم از ارزش اصلی آن است. سپس تعداد میکروارگانیسمها پس از زمان استرلیزاسیون توسط فرمول زیر تعیین میشود:
مقدار D تابعی از شرایط استرلیزاسیون است و با نوع میکروارگانیسم، دما، فعالیت آب، pH و غیره متفاوت است. برای استرلیزاسیون بخار معمولاً دما، برحسب درجه سانتیگراد، به صورت شاخص در نظر گرفته میشود. از نظر تئوری، احتمال زنده ماندن یک میکروارگانیسم فردی هرگز صفر نیست. برای جبران این امر، اغلب از روش اضافه بار استفاده میشود. با استفاده از روش اضافه بار، استرلیزاسیون با استرلیزاسیون به مدت طولانیتر از زمان مورد نیاز برای از بین بردن بارهای زیستی موجود بر روی یا در مورد مورد استریل انجام میشود.
این یک سطح اطمینان در سترونسازی (SAL) را برابر با احتمال یک واحد غیر استریل ارائه میدهد. برای برنامههای پرخطر، مانند دستگاههای پزشکی و تزریق، سطح اطمینان از نازایی حداقل 10 - 6 توسط اداره غذا و داروی ایالات متحده (FDA) مورد نیاز است. حرارت خشک اولین روش استرلیزاسیون بود و فرایندی طولانی تر از استرلیزاسیون با حرارت مرطوب است. تخریب میکروارگانیسمها از طریق استفاده از گرمای خشک یک پدیده تدریجی است. با قرار گرفتن طولانیتر در معرض دمای کشنده، تعداد میکروارگانیسمهای کشته شده افزایش مییابد.

میتوان از تهویه اجباری هوای گرم برای افزایش سرعت انتقال گرما به یک موجود زنده و کاهش دما و زمان مورد نیاز برای دستیابی به استریل شدن استفاده کرد. در دماهای بالاتر، زمان کوتاهتری برای استریل کردن لازم است. تنظیمات استاندارد برای اجاق هوای گرم حداقل دو ساعت در دمای 160 درجه سانتیگراد است. برای انجام سریع، هوا را تا 190 درجه سانتیگراد به مدت 6 دقیقه برای اجسام باز نشده و 12 دقیقه برای اجسام پیچیده گرم میکند. گرمای خشک این مزیت را دارد که میتوان از آن برای پودرها و سایر اقلام پایدار در برابر حرارت که تحت تأثیر بخار قرار میگیرند استفاده کرد.
استرلیزاسیون در آزمایشگاه میکروبیولوژی توسط مواد شیمیایی با اتیلن اکساید، نیتروژن دیاکسید، اوزون، هیدروژن پراکسید، گلوتارآلدهید و فرمالدئید و پاراستیک اسید انجام میشود. عقیم سازی را میتوان با استفاده از تشعشعات الکترومغناطیسی مانند اشعه ماوراء بنفش، اشعه ایکس و اشعه گاما یا تابش توسط ذرات زیر اتمی مانند پرتوهای الکترون انجام داد. تابش الکترومغناطیسی یا ذرات معلق میتواند به اندازه کافی پر انرژی باشد تا اتمها یا مولکولها (تابش یونیزه کننده) یا کمتر پرتوزا (تابش غیر یونیزه کننده) باشد.
مایعاتی که در اثر حرارت، تابش یا استرلیزاسیون شیمیایی مانند محلول دارویی آسیب میبینند، میتوانند با استفاده از فیلترهای غشایی با میکروفیلتراسیون استریل شوند. ابزارهایی که تحت استرلیزاسیون قرار گرفتهاند را میتوان با نگهداری در بستهبندی تا زمان استفاده نگهداری کرد. تکنیک آسپتیک عمل حفظ نازایی در طول عمل است.
ضد عفونی کردن در آزمایشگاه میکروبیولوژی
ضد عفونی کردن (Disinfection) نیز فرآیندی برای از بین بردن یا مهار رشد باکتریها یا سایر عوامل بیماریزا (میکروارگانیسمها) از اجسام یا سطوح بیجان استفاده میشود. از مواد ضد عفونیکننده مانند الکل، کلر و غیره استفاده میشود تا این ماده و سطح آن عاری از عفونت باشد. متداولترین ضد عفونیکنندههای آزمایشگاهی شامل سفیدکننده (هیپوکلریت)، اتانول (70٪، حجمی) و انواع آمادهسازی تجاری مانند وسکودین است. میتوان مواد ضد عفونیکننده مفید را روی سطوح آزمایشگاهی اسپری و پس از مدت کوتاهی با حولههای کاغذی تمیز کرد.
سطح فعالیت مواد شیمیایی کشنده به ترتیب زیر هستند:
- ضد عفونی سطح بالا:
- شامل غلظت بالای میکروبکشهای شیمیایی مانند هیپوکلریت سدیم غلیظ است.
- میکروارگانیسمهای رویشی را از بین میبرد و ویروسها را غیرفعال میکند.
- تعداد زیادی از اسپورهای باکتریایی را از بین نمیبرد.
- ضد عفونیکنندههای سطح بالا معمولاً برای دورههای کوتاه مدت (10 تا 30 دقیقه) برای اهداف ضد عفونی استفاده میشوند اما در صورت تماس طولانی مدت با سطح (6 تا 10 ساعت) ممکن است به استرلیزاسیون برسند.
- برای سطوح محیطی مانند کف یا میزهای آزمایشگاهی استفاده نمیشود.
- ضدعفونی سطح متوسط:
- میکروارگانیسمهای رویشی از جمله مایکوباکتریوم توبرکلوزیس و همه قارچها را از بین میبرد و اکثر ویروسها را غیر فعال میکند.
- ضد عفونیکنندههای بیمارستانی مورد تأیید سازمان حفاظت محیط زیست (EPA) که توبرکلوئیدی هستند، در این دسته قرار میگیرند.
- ممکن است برای نظافت و ضدعفونی میزهای آزمایشگاهی استفاده شود.
- ضد عفونی سطح پایین:
- اکثر باکتریهای رویشی، برخی قارچها را از بین میبرد و برخی از ویروسها را غیرفعال میکند.
- مایکوباکتریوم توبرکلوزیس را از بین نمیبرد.
- به نام ضد عفونیکننده بیمارستانی یا پاککننده شناخته میشود.

کشت میکروب در آزمایشگاه میکروبیولوژی
پنج روش اولیه آزمایشگاه میکروبیولوژی وجود دارند که توسط میکروبیولوژیستها برای بررسی و مشخصه میکروبها مانند تلقیح، انکوباسیون، جداسازی، بازرسی (مشاهده) و شناسایی استفاده میشوند. برای کشت یک میکروارگانیسم، یک نمونه کوچک معمولاً با کمک یک کاوشگر سیم پلاتینی روی سطح آن به یک محیط کشت منتقل میشود.
تلقیح و انکوباسیون در آزمایشگاه میکروبیولوژی
تکنیکی که از طریق آن یک میکروارگانیسم خاص برای ایجاد کلونیها به محیط کشت وارد میشود، تلقیح نام دارد. متداولترین روش برای پخش، حلقه استریل شده با حرارت یا میکروپیپت با نوک استریل است. روش ورق ریختن، روش ورق پخش و روش ورقه ورقه همه در تکنیکها گنجانده شدهاند. پس از اتمام تلقیح، آگار یا آبگوشت حاوی تلقیح در مدت زمان مورد نیاز در دستگاه انکوباسیون در دمای معینی نگهداری میشود. این از رشد مطلوب باکتریها پشتیبانی میکند.
کنترل کیفی در آزمایشگاه میکروبیولوژی
کنترل کیفی به کنترل مواد، محیط و آزمایشات انجام شده در آزمایشگاه میکروبیولوژی اشاره دارد. هر آزمایشگاه باید دارای سیستم جامع کنترل کیفیت برای هریک از فعالیتهای تشخیصی خود باشد. این شامل تولید محیط کشت، آزمایشهای شناسایی، آزمایشهای حساسیت به آنتی بیوتیکها، سنجش آنتی بیوتیکها و تکنیکهای سرولوژی میشود. مباحث مربوط به کنترل کیفیت در این زمینه ها در فصلهای مربوط به تفصیل بیشتر مورد بحث قرار خواهد گرفت.
کیفیت محیط کشتهای میکروبیولوژیکی در ارزش یک آزمایشگاه بسیار مهم است. یک محیط غنی سازی که از نظر تغذیه کافی برای حمایت از عامل بیماریزا هدف ندارد، منجر به بسیاری از کشتهای منفی کاذب میشود. اگر یک محیط انتخابی بیش از حد مهارکننده پاتوژن و همچنین فلور طبیعی باشد، یک وضعیت مشابه ایجاد میشود. با این حال، اگر محیط به اندازه کافی مهارکننده نباشد، ارگانیسمهای همجنس گرا بیش از حد روی صفحه را پنهان میکنند و پاتوژن مورد نظر را پنهان میکنند. کیفیت محیط کشت را میتوان از دو طریق کنترل کرد:
- کنترل فرآیند
- کنترل دستهای
کنترل دستهای اغلب به عنوان کنترل کیفیت نامیده میشود. کنترل فرآیند بستگی به داشتن مجموعهای از روشهای استاندارد عملکرد برای کارکرد تجهیزات مورد استفاده در تولید محیط کشت، انکوباسیون، روشها و دستورالعملهایی دارد که تولید محیط کشت را توصیف میکند، اعم از تولید کننده تجاری یا داخلی. کیفیت معرفهایی که از طریق pH آب و محتوای یون وارد محیط میشوند نیز باید به روشنی مشخص شده و روشهای اندازهگیری و در صورت لزوم رد دستهها تعیین شود. در کنترل دستهای دو مورد باید در نظر گرفته شوند: ویژگیهای فیزیکی محیط و عملکرد میکروبیولوژیکی آن.

ویژگیهای فیزیکی باید شامل ظاهر محیط باشد: یک صفحه آگار خون که گلبولهای قرمز در آن قرار گرفتهاند برای آزمایش همولیز رضایت بخش نیست. ظاهر فیزیکی و محدودیتهای تنوع باید در روش شرح داده شود. اگر ژل بسیار سفت باشد، محیط باید دارای ژل کافی باشد، رشد ضعیف و کلونیها کوچک خواهد بود. برعکس کار با محیط نرم بسیار مشکل است زیرا تمایل به پاره شدن دارد. محیط باید در pH آن کنترل شود زیرا انحراف در این معیار مهم منجر به رشد ضعیف موجودات حساس به pH میشود. این را میتوان با یک pH متر ساده آزمایش کرد.
محیط جداسازی و شناسایی باید به طور قابل اطمینان استریل باشد، بنابراین نمونهها از هر دسته ریخته شده باید قبل از رهاسازی دسته در دمای 37 درجه سانتیگراد و در دمای اتاق آزمایش شوند. عمر مفید محیط کشتها همراه با یک سیستم کنترل ایجاد میشوند. عملکرد میکروبیولوژیکی محیطها باید با پانلی از موجودات استاندارد کنترل شود. اینها ممکن است به صورت محلی تأسیس شوند.
از محیط کشتهای استاندارد برای اطمینان از این که مواد مغذی به اندازه کافی برای حمایت از رشد عوامل بیماریزا سریع استفاده میشود، استفاده میشود. این ممکن است با انجام یک شمارش مناسب از رشد یک شبه یک ارگانیسم کنترل یا با روش مایلز و میسرا یا شمارش کلونیها پس از یک روش استاندارد به دست آید. علاوه بر نشان دادن حمایت تغذیهای کافی، ظاهر یا واکنشهای مشخصی نیز باید وجود داشته باشد، به عنوان مثال بتا همولیز یا کلونیها رنگی به دلیل تغییرات شاخص. برای محیط کشتهای انتخابی باید توانایی سرکوب موجودات ناخواسته را به موازات حمایت از ارگانیسمهای هدف نشان داد.
وسایل آزمایشگاه میکروبیولوژی عمومی
ابزارهای مورد استفاده در آزمایشگاههای میکروبیولوژی شامل مجموعه ای از انواع مختلف ابزار مورد نیاز برای بسیاری از فرایندهای مختلف است که در آن آزمایشگاهها انجام میشود.

هموژنایزر
هموژنایزر دستگاهی است که در آزمایشگاه میکروبیولوژی برای مخلوط کردن مایعات و مواد مختلف مانند بافت، گیاه، غذا، خاک و بسیاری دیگر مورد استفاده قرار میگیرد. این ابزار بر این اصل استوار است که وقتی گلولههای بزرگ در امولسیون درشت تحت فشار زیاد از یک دهانه باریک عبور میکنند، به ذرات کوچکتر تجزیه میشوند و مخلوط یکنواخت و پایداری ایجاد میکنند. یک هموژنایزر دارای یک میله فلزی با دهانههای موازی باریک به شکل یک شانه در انتها است که به عنوان دهانه فرایند همگن سازی عمل میکند.
هموژنایزر در درجه اول برای ایجاد اختلال در سلولها برای به دست آوردن اندامکهای سلولی برای فرایندهای مختلف میکروبیولوژیکی استفاده میشود. در مرحله آمادهسازی قبل از استخراج و تصفیه ماکرومولکولهای مختلف مانند پروتئینها، اسیدهای نوکلئیک و لیپیدها استفاده میشود.
ورتکس
ورتکس یکی از فناوریهای اساسی است که برای مخلوط کردن نمونهها در لولههای شیشهای یا فلاسک در آزمایشگاهها استفاده میشود. کار ورتکس بر اساس اصل ساده ایجاد واکنش و همگن شدن با هم زدن مخلوط است. شفتهای پیشران موتوری موجود بر روی میکسر نوسان میکند و حرکت را به لولههای نمونه منتقل میکند و باعث میشود سیالات نمونه دچار جریان آشفتهای شوند. ورتکس بیشتر برای مخلوط کردن مایعات نمونه مختلف در لولههای نمونه استفاده میشود و همچنین امکان همگنسازی سلولها و اندامکهای سلولی را فراهم میکند.
چراغ بنزن
چراغ بنزن (Bunsen Burner) یک ابزار استاندارد و شعله باز با سوخت گاز است. اصل کار این مشعل با یک لوله فلزی روی یک پایه صاف با یک ورودی گاز در پایین لوله ساخته شده است که ممکن است دارای یک شیر قابل تنظیم باشد. در کنارههای لوله دهانههایی وجود دارد که میتوان آنها را با یقه تنظیم کرد تا میزان هوای ورودی را کنترل کند. هنگامی که مشعل به منبع گاز متصل و کبریت یا فندک به بالای آن میرسد، شعلهور میشود. چراغ بنزن معمولاً برای فرآیندهایی مانند استرلیزاسیون، احتراق و گرمایش استفاده میشود. در آزمایشگاههای پزشکی یا میکروبیولوژی، معمولاً برای استرلیزاسیون حلقههای کوچک از این ابزار استفاده میشود.

تراز تحلیلی
تراز تحلیلی نوعی از دستگاه وزنگیری است که معمولاً برای اندازهگیری جرم در محدوده زیر میلیگرم استفاده میشود. این نوع ترازوها با یک تابه اندازهگیری در یک پوشش شفاف ساخته شده است که از جمع شدن ذرات ریز یا جریان هوا بر روی تابه جلوگیری میکند. تراز الکتریکی تحلیلی از نیروی لازم برای مقابله با جرم به جای اندازهگیری خود جرم استفاده میکند. از الکترومغناطیس برای ایجاد نیروی مورد نیاز برای دستیابی به تعادل با جرم ماده استفاده و نیروی حاصله نمایش داده میشود.
از آنجا که ترازهای تحلیلی بسیار دقیق و بر اساس فناوری پیشرفته هستند، در آزمایشگاه میکروبیولوژی برای وزن مواد آزمایش و مقدار نمونهبرداری، فرمول بندی، تعیین چگالی، تجزیه و تحلیل خلوص، آزمایش کنترل کیفیت و آزمایش مواد و انطباق استفاده میشود.
شمارنده کلونی
از شمارش کلونیها برای برآورد چگالی کشت مایع با شمارش تعداد CFU (واحدهای تشکیلدهنده کلونی) بر روی صفحات آگار یا کشت استفاده میشود. این دستگاه میتواند اندازههای مختلفی از صفحات را که در بالا با اشعه ماوراء بنفش، نور سفید یا روشنایی فلورسنت اسکن شدهاند، در خود جای دهد. میتوان شمارش را به صورت دستی با فشار لمسی یا با شمارنده دیجیتال انجام داد. شمارنده کلونی در درجه اول برای شمارش تعداد کلونیها موجود در یک صفحه کشت برای تخمین غلظت میکروارگانیسمها در کشت مایع استفاده میشود.

فریزر عمیق
فریزرهای عمیق بر این اصل استوارند که در دماهای بسیار پایین، حداقل رشد میکروبی وجود دارد که امکان محافظت و حفظ مواد مختلف را فراهم میکند. بر اساس این اصل، حتی میتوان محیط کشتها را در مدت زمان طولانی بدون تغییر در غلظت میکروارگانیسمها حفظ کرد. از انجماد عمیق میتوان برای حفظ چیزهای مختلف مورد استفاده در آزمایشگاهها برای مدت زمان طولانی استفاده کرد. فریزرهای عمیق در آزمایشگاه میکروبیولوژی برای ذخیره و نگهداری تجهیزات پزشکی استفاده میشوند.
سانتریفیوژ
سانتریفیوژ دستگاهی است که امکان چرخش یک جسم در یک محور واحد را فراهم میکند، جایی که نیروی خارجی به صورت عمود بر محور وارد میشود. سانتریفیوژ آزمایشگاهی مبتنی بر موتور است و امکان چرخش نمونه مایع را فراهم میکند که منجر به جداسازی اجزای مخلوط میشود. سانتریفیوژ بر اساس نیروی گریز از مرکز و ویژگیهای رسوبی مواد کار میکند. سرعت زیاد چرخش باعث میشود ذرات متراکمتر از مرکز دور شوند در حالی که ذرات کوچکتر و متراکم کمتر به سمت مرکز مجبور میشوند. بنابراین، ذرات متراکمتر در پایین ته نشین میشوند در حالی که ذرات سبک تر در بالا جمع میشوند.
در سانتریفیوژ رومیزی آزمایشگاهی، لولههای نمونه با زاویه ای تراز شدهاند تا ذرات مجبور شوند مسافت کوتاهی را قبل از برخورد به پایین طی کنند. کاربرد اصلی سانتریفیوژ جداسازی ذرات معلق در یک سوسپانسیون است. میتوان از آن برای جداسازی اندامکهای سلولی، اسید نوکلئیک، اجزای خون و جداسازی ایزوتوپها استفاده کرد.

انکوباتور چیست؟
انکوباتور دستگاهی است که در آزمایشگاهها برای رشد و نگهداری میکروارگانیسمها و محیط کشتها مورد استفاده قرار میگیرد. دستگاه انکوباتور دمای مطلوب، فشار، رطوبت و سایر موارد مورد نیاز برای رشد میکروارگانیسمها را فراهم میکند. اصل کار انکوباتور بر اساس اصل حفظ جو مناسب برای رشد میکروارگانیسمها است. انکوباتورها دارای سیستم گرمایشی هستند که اجازه میدهد درجه حرارت داخل دستگاه انکوباتور با توجه به نوع موجود زنده کشت شده در داخل تنظیم شود.
به طور مشابه، تنظیماتی برای حفظ غلظت CO2 در نظر گرفته میشود تا PH و رطوبت مورد نیاز برای رشد موجودات زنده متعادل شود. انواع انکوباتور وجود دارند به طور مثال انکوباتور شیکر با حرکت مداوم محیط کشت مورد نیاز برای مطالعات هوادهی و حلالیت سلولی را میدهد. انکوباتور کاربردهای وسیعی از جمله کشت سلولی، مطالعات دارویی، مطالعات هماتولوژیکی و مطالعات بیوشیمیایی دارد. از انکوباتور میتوان در منطقه تحقیقات سلول بخار نیز استفاده کرد. انکوباتور میکروبی از واحدهای مختلفی تشکیل شده است که برخی از آنها عبارتند از:
- کابینت: بدنه اصلی دستگاه انکوباتور شامل محفظه مکعبی دو جداره با ظرفیت 20 تا 800 لیتر است. دیوار خارجی از ورق های فولادی ضد زنگ و دیوار داخلی از آلومینیوم ساخته شده است. فضای بین دو دیوار با پشم شیشه پر شده است تا عایق حرارت دستگاه انکوباتور باشد. عایق از اتلاف گرما جلوگیری میکند و به نوبه خود، مصرف برق را کاهش میدهد، در نتیجه از کار روان دستگاه اطمینان حاصل میشود. دیواره داخلی دستگاه انکوباتور دارای سطوح داخلی است که قفسههای موجود در داخل دستگاه انکوباتور را پشتیبانی میکند.
- در: برای بستن کابینت عایق درب در همه انکوباتورها وجود دارد. درب نیز عایق مخصوص به خود را دارد. همچنین دارای شیشه ای است که امکان تجسم فضای داخلی انکوباتور را در حین انکوباتور بدون ایجاد مزاحمت در محیط داخلی فراهم میکند. دستهای در قسمت بیرونی درب وجود دارد که به مانور درب کمک میکند.
- صفحه کنترل: در دیواره بیرونی انکوباتور یک صفحه کنترل با تمام کلیدها و نشانگرها وجود دارد که به شما امکان میدهد پارامترهای دستگاه انکوباتور را کنترل کنید. همچنین صفحه کنترل جهت کنترل ترموستات دستگاه است.
- ترموستات: برای تنظیم دمای مطلوب انکوباتور از ترموستات استفاده میشود. پس از رسیدن به دمای مورد نظر، ترموستات به طور خودکار انکوباتور را در آن دما نگه می دارد تا زمانی که دوباره دما تغییر کند.
- قفسههای سوراخ دار: قفسههای سوراخ شدهای که صفحات با محیط کشت روی آنها قرار گرفته است به دیوار داخلی متصل شده است. سوراخهای روی قفسهها اجازه میدهد تا هوای گرم در سراسر داخل انکوباتور حرکت کند. در برخی از انکوباتورها قفسهها قابل جابجایی هستند که باعث میشود قفسهها به درستی تمیز شوند.
- واشر: درب آزبست واشر درب آزبست باعث ایجاد مهر و موم تقریباً درب بین در و کابینت میشود. این مهر و موم از ورود هوای خارجی به داخل کابینت جلوگیری میکند و بنابراین، محیط گرم جدا شدهای را در داخل کابینت ایجاد میکند بدون اینکه توسط محیط خارجی قطع شود.
- دماسنج L شکل: یک دماسنج در قسمت بالای دیواره بیرونی انکوباتور قرار داده شده است. یک سر دماسنج مجهز به درجهبندی در خارج از انکوباتور باقی میماند تا دما به راحتی خوانده شود. انتهای بعدی با پیاز جیوه کمی به محفظه دستگاه انکوباتور بیرون زده است.
- فیلترهای HEPA: برخی از انکوباتورهای پیشرفته دارای فیلترهای HEPA هستند تا آلودگی احتمالی ایجاد شده در اثر جریان هوا را کاهش دهند. یک پمپ هوا با فیلترها یک سیستم حلقه بسته ایجاد میکند به طوری که جریان هوا در داخل انکوباتور آلودگی کمتری ایجاد میکند.
- رطوبت و کنترل گاز: انکوباتورهای CO2 دارای مخزنی در زیر محفظهای هستند که حاوی آب است. آب برای حفظ رطوبت نسبی داخل محفظه بخار میشود. به طور مشابه، این انکوباتورها نیز دارای محفظههای گاز هستند تا غلظت دلخواه CO2 را در داخل انکوباتور ایجاد کنند.

کار با انکوباتور در آزمایشگاه میکروبیولوژی
پس از ایجاد محیط کشت، صفحات کشت باید در داخل دستگاه انکوباتور در دمای مطلوب و مدت زمان مورد نیاز قرار گیرند. در اکثر آزمایشگاههای بالینی، دمای معمول برای باکتریها 35-37 درجه سانتیگراد است. مراحل زیر هنگام اجرای دستگاه انکوباتور باید انجام شود:
- قبل از استفاده از دستگاه انکوباتور، باید مطمئن شوید که هیچ اقلام باقیماندهای در دوره های قبلی در دستگاه انکوباتور وجود نداشته باشد. با این حال، در برخی موارد، اگر از دستگاه انکوباتور یکسان برای موجودات متعدد استفاده میشود، و آنها نیاز به مجموعهای از پارامترها دارند، میتوان آنها را در یک دستگاه انکوباتور یکجا قرار داد.
- سپس درب دستگاه انکوباتور بسته میشود و دستگاه انکوباتور روشن میشود. دستگاه انکوباتور باید تا دمای مطلوب رشد ارگانیسم خاص گرم شود. میتوان از دماسنج برای بررسی اینکه آیا درجه حرارت رسیده است استفاده کرد.
- در عین حال، اگر ارگانیسم به غلظت خاصی از CO2 یا رطوبت خاصی نیاز داشته باشد، این پارامترها نیز باید در دستگاه انکوباتور تنظیم شوند.
- هنگامی که همه پارامترها برآورده میشوند، محیط کشت پتری دیش برعکس روی قفسههای سوراخدار قرار میگیرد، یعنی بالای محیط کشت. این امر ضروری است زیرا اگر صفحات به طور عادی انکوباتور شوند، تراکم روی سطح محیط جمع شده و از تشکیل کلونیهای جدا شده جلوگیری میکند.
- در صورت لزوم انکوبه کردن محیط کشت ظرف پتری برای چند روز، صفحات با نوار چسب بسته میشوند یا در کیسههای پلاستیکی یا ظروف پلاستیکی مواد غذایی قرار میگیرند.
- اکنون در قفل شده است و پتریدیشها قبل از بیرون آوردن آنها برای مدت زمان مورد نیاز در داخل نگهداری میشوند.

انواع انکوباتور
بر اساس وجود یک پارامتر خاص یا هدف، انکوباتورها به انواع زیر تقسیم میشوند.
- انکوباتور بنچ: رایجترین نوع انکوباتور است که در اکثر آزمایشگاهها استفاده میشود و انواع اولیه انکوباتور با کنترل دما و عایق هستند.
- انکوباتور CO2: دستگاههای انکوباتور CO2 (کربندیاکسید) انواع خاصی از دستگاه های انکوباتور هستند که با کنترل خودکار کربندیاکسید و رطوبت ارائه میشوند. این نوع دستگاه انکوباتور برای رشد کشت باکتریهای مختلف که نیاز به 5 تا 10 درصد غلظت کربندیاکسید دارند مورد استفاده قرار میگیرد. برای کنترل رطوبت، آب در زیر کابینت دستگاه انکوباتور نگهداری میشود.
- انکوباتور سرد: برای انکوباتور در دمای زیر محیط، انکوباتورهای مجهز به سیستم های تبرید اصلاح شده با کنترل های گرمایش و سرمایش هستندکه به آن انکوباتور خنککننده میگویند. در دستگاه انکوباتور خنککننده، کنترلهای گرمایش و سرمایش باید به طور مناسب متعادل باشند.
- انکوباتور شیکر: انکوباتور کنترل کننده ترموستاتیکی دستگاه دیگری است که برای کشت میکروارگانیسم ها استفاده میشود. مزیت آن این است که انتقال سریع و یکنواخت گرما را به ظرف کشت ارائه میدهد و همزن آن باعث افزایش هوادهی و در نتیجه تسریع رشد میشود. با این حال، این نوع انکوباتور فقط میتواند برای آبگوشت یا محیط کشت مایع استفاده شود.
- انکوباتور قابل حمل: انکوباتورهای قابل حمل از نظر اندازه کوچکتر هستند و در کارهای میدانی استفاده میشوند، به عنوان مثال میکروبیولوژی محیطی و بررسی آب.
موارد استفاده از انکوباتور
انکوباتور کاربردهای وسیعی در زمینه های مختلف از جمله کشت سلولی، مطالعات دارویی، مطالعات خون شناسی و مطالعات بیوشیمیایی دارند. برخی از کاربردهای دستگاه انکوباتور در زیر آورده شده است:
- رشد کشت میکروبی یا کشت سلولی
- حفظ محیط کشت موجودات زنده تا زمان استفاده
- برخی از دستگاههای انکوباتور برای افزایش سرعت رشد موجودات زنده استفاده میشوند که دارای سرعت رشد طولانی مدت در محیط طبیعی هستند.
- از انکوباتورهای مخصوص برای تولید مثل کلونیهای میکروبی و متعاقباً تعیین نیاز اکسیژن بیوشیمیایی استفاده میشود. همچنین برای پرورش حشرات و تخمگذاری در جانورشناسی مورد استفاده قرار میگیرند.
- فراهم کردن شرایط کنترل شده را برای ذخیره نمونه قبل از پردازش در آزمایشگاهها
هود لامینار
هود لامینار یک دستگاه بسته است که عمدتا برای فرآیندها یا ابزارهای حساس به آلودگی میکروبی است. هود لامینار از فولاد ضد زنگ ساخته شده است و از اتصالات و گوشه ها جلوگیری میکند تا از تجمع اسپورهای باکتری جلوگیری شود. این دستگاه با جریان هوای استریل از طریق فیلتر هوای ذرات معلق با کارایی بالا (HEPA) و لامپ میکروبکش ماوراء بنفش موج کوتاه که محل کار را استریل میکند.
جریان هوای لامینار باید 15 دقیقه قبل روشن شود تا از استرلیزاسیون کامل اطمینان حاصل شود و محل کار باید قبل و بعد از استفاده با اتانول تمیز شود. هود لامینار معمولاً برای انجام فرآیندهای حساس به آلودگی استفاده میشود. برای آزمایشات مربوط به کشت بافت گیاهی و آزمایشهای تغییر ژنتیک استفاده میشود.

Hot plate
صفحه گرم یک دستگاه مستقل است که در آزمایشگاه میکروبیولوژی به عنوان سیستم گرمایش روی میز استفاده میشود. برخلاف روشهای سنتی تولید گرما از طریق آتش، یک صفحه داغ با جریان الکتریسیته گرما تولید میکند. در صفحه داغ، الکتریسیته از سیمپیچهایی که دارای مقاومت الکتریکی بالایی هستند عبور میکند. مقاومت در سیمپیچها انرژی الکتریکی را به انرژی گرمایی تبدیل میکند که باعث میشود سیمپیچها گرما را آزاد کنند. در آزمایشگاه میکروبیولوژی از صفحات داغ برای گرم کردن ظروف شیشه ای و اجزای آنها استفاده میشود. آنها در حمامهای آبی استفاده میشوند زیرا در حمام های آب ممکن است در صورت نشت یا گرم شدن بیش از حد خطرناک باشد.
آون هوای گرم
کوره هوای گرم یک دستگاه الکتریکی است که برای استرلیزاسیون تجهیزات پزشکی یا نمونه ها با استفاده از حرارت خشک استفاده میشود. کوره هوای گرم نوعی استرلیزاسیون با حرارت خشک است که روی مواد خشک و موادی که در دمای بالا ذوب نمیشوند و آتش نمی گیرند، انجام میشود. دو نوع اجاق گاز بر اساس اصل کار وجود دارد
اجاق گاز هوای گرم اجباری: در این نوع اجاقهای هوای گرم، هوای گرم شده داخل فر با یک فن در سراسر فر توزیع میشود. این مانع از بالا آمدن هوای گرم به سمت بالا میشود در حالی که هوای سرد در پایین نگه داشته میشود. این امر باعث گرم شدن کافی مواد داخل فر میشود.
کوره هوای گرم هوای ساکن: در این نوع فرها، گرما توسط کویل های موجود در ته فر بدون فن تولید میشود. هوای گرم بالا می رود و اجازه استرلیزاسیون موثر مواد را نمیدهد. تجهیزات داخل کوره گرما می گیرند و گرما را به مرکز منتقل میکنند، یک لایه در یک زمان که امکان استرلیزاسیون موثر حرارت خشک را فراهم میکند. از اجاق گاز گرم میتوان برای استرلیزاسیون موادی مانند ظروف شیشهای، تجهیزات فلزی، پودرها و غیره استفاده کرد. این میتواند میکروارگانیسمها و اسپورهای باکتریایی را از بین ببرد.
همزن مغناطیسی
همزن مغناطیسی (Magnetic Stirrer) دستگاهی است که معمولاً در آزمایشگاههای میکروبیولوژی به منظور مخلوط کردن مایعات استفاده میشود. این دستگاه شامل یک مغناطیسی چرخشی یا یک آهنربای الکترومغناطیسی است که یک میدان مغناطیسی دوار ایجاد میکند و به نوار همزن (قطعه ای از فلزات سنگین) اجازه میدهد در ظرف حرکت کند. آن را با یک سیستم گرمایش همراه میکند تا مایع را هنگام مخلوط شدن گرم کند. معمولاً برای مخلوط کردن اجزای مختلف مایع در مخلوط در آزمایشگاه شیمی یا میکروبیولوژی استفاده میشود. این دستگاه به جای دیگر همزنها استفاده میشود زیرا بدون سر و صدا است و چون اندازه نوار همزن بسیار کوچک است، احتمال آلودگی کاهش مییابد.

میکروسکوپ
انواع مختلفی از میکروسکوپ در آزمایشگاه میکروبیولوژی وجود دارند که هر کدام بر اساس اصول خاص خود کاربردهای متنوعی دارند، با این حال، اشتراکاتی نیز در آنها وجود دارند. اصل اساسی در میکروسکوپ بزرگنمایی است. بر اساس موقعیت نسبی جسم از لنز یا الکترومغناطیس، میتوان موقعیتهای مختلف، ماهیت و بزرگنمایی تصویر را به دست آورد.
حمام آب
حمام آب یک دستگاه معمولی است که برای واکنش های شیمیایی مورد استفاده قرار میگیرد و نیاز به یک محیط کنترل شده در دمای ثابت دارد. یک حسگر در دستگاه دمای آب را به یک مقدار مرجع منتقل میکند که سپس تقویت میشود و یک سیستم کنترل سیگنالی برای سیستم گرمایش ایجاد میکند که آب را به دمای دلخواه گرم میکند. حمام آب در درجه اول برای گرم کردن نمونهها در دمای کنترل شده استفاده میشود. اینها برای گرم کردن مواد شیمیایی مناسب هستند که در صورت احتراق مستقیم قابل اشتعال هستند.
اتوکلاو
اتوکلاو یک محفظه تحت فشار است که برای ترکیب استرلیزاسیون و ضد عفونی با ترکیب سه عامل زمان، فشار و بخار استفاده میشود. اصل کار اتوکلاوها از بخار به عنوان عامل ضد عفونیکننده خود استفاده میکنند. همه اقلام داخل اتوکلاو بدون در نظر گرفتن ماهیت مواد (مایع، ظروف پلاستیکی یا ظروف شیشهای) برای یک دوره خاص در تماس مستقیم با بخار قرار میگیرند.
مقدار زمان و دما بستگی به نوع ماده استریل شده دارد و افزایش دمای چرخه باعث دورههای کوتاهتری میشود. اتوکلاوها بیشتر برای استرلیزاسیون تجهیزات پزشکی یا آزمایشگاهی با قابلیت استریل کردن تعداد زیادی از مواد به طور همزمان استفاده میشوند. همچنین در آزمایشگاه میکروبیولوژی به صورت اختصاصی برای تهیه محیط کشت کاربرد دارند.

دستگاه تقطیر آب
دستگاه تقطیر آب دستگاهی است که آب را با فرآیند تقطیر تصفیه میکند. این ابزار معمولاً در آزمایشگاههای پزشکی، آزمایشگاههای میکروبیولوژی، آزمایشگاههای شیمی آلی و صنایع پزشکی استفاده میشود. تقطیر کننده آب بر اساس اصل تقطیر است. طبق این فرایند، ابتدا آب را به جوش آورده و سپس به شکل مایع تغلیظ کرده تا آب مقطر خالص به دست آید. برای به دست آوردن آب مقطر مورد نیاز برای بسیاری از آزمایشات آزمایشگاهی و همچنین برای تهیه محیط کشت استفاده میشود.
pH متر
pH متر دستگاهی است که در آزمایشگاهها مورد استفاده قرار میگیرد و غلظت یون هیدروژن را در محلولهای مبتنی بر آب اندازهگیری میکند تا اسیدیته یا قلیائیت محلول تعیین شود. pH متر اغلب به عنوان pH متر پتانسیومتری نامیده میشود زیرا تفاوت پتانسیل الکتریکی بین الکترود مرجع و pH را اندازهگیری میکند. در pH سنج پتانسیومتری، الکترودهای شیشه ای تک یا چندگانه، متصل به یک لامپ انتخابی برای یونهای هیدروژن، به یک میله فلزی متصل میشوند.
هنگامی که لامپ با الکترودها در محلول فرو میرود، یونهای هیدروژن در محلول با بارهای مثبت روی الکترود تبادل میکنند و پتانسیل الکتروشیمیایی ایجاد میکنند که بر حسب واحد های pH نمایش داده شده نمایش داده میشود. pH متر در درجه اول برای اندازهگیری اسیدیته مواد شیمیایی دارویی، کشت، خاک و تصفیه خانه آب استفاده میشود.

اسپکتروفتومتر
دستگاه اسپکتروفتومتر یک ابزار نوری برای اندازهگیری شدت نور نسبت به طول موج است. بر اساس میزان جذب نور توسط یک محلول رنگی، تجزیه و تحلیل کمی از محلول میتواند انجام شود. طیف سنجی بر اساس قانون بیر-لمبرت است که بیان میکند جذب نور توسط یک محلول (با طول موج خاص) مستقیماً با غلظت ماده متناسب است.
طول موج های مختلف چراغها از طریق محلول عبور میکنند زیرا مواد مختلف جذب بهتری در طول موج های مختلف دارند. بر اساس جذب طول موج خاص، تجزیه و تحلیل کمی یک محلول را میتوان انجام داد. در آزمایشگاه میکروبیولوژی، دستگاه اسپکتروفتومتر برای اندازهگیری غلظت ماده پروتئین، اسیدهای نوکلئیک، رشد باکتریها و واکنشهای آنزیمی استفاده میشود.
استریلیزاسیون توسط دستگاه اتوکلاو
اتوکلاو دستگاهی است که با از بین بردن باکتریها، ویروسها و حتی اسپورهای موجود در موادی که در داخل ظرف با استفاده از بخار تحت فشار قرار می گیرند، استریلیزاسیون را انجام میدهد. اتوکلاو مواد را با گرم کردن آنها تا دمای خاص برای مدت زمان مشخص استریل میکند. اتوکلاو ضدعفونیکننده بخار نیز نامیده میشود که معمولاً در مراکز بهداشتی درمانی و صنایع برای اهداف مختلف استفاده میشود. اتوکلاو به عنوان روش مؤثرتری برای استریلیزاسیون در نظر گرفته میشود زیرا بر اساس استریلیزاسیون با حرارت مرطوب است. سادهترین شکل اتوکلاو انواع زودپز یا اتوکلاو بنچ آزمایشگاهی است. در زیر توضیحات مفصل اجزای مختلف و قطعات اتوکلاو آمدهاند.
اتاق فشار: محفظه فشار جزء اصلی اتوکلاو بخار است که از یک محفظه داخلی و یک ژاکت بیرونی تشکیل شده است. محفظه داخلی از فولاد ضد زنگ یا فلز اسلحه ساخته شده است که در داخل محفظه بیرونی ساخته شده از یک قاب آهنی وجود دارد. اتوکلاوهایی که در آزمایشگاههای مراقبتهای بهداشتی استفاده میشوند دارای یک ژاکت بیرونی هستند که با بخار پر میشود تا زمان لازم برای رسیدن به دمای استرلیزاسیون کاهش یابد. محفظه داخلی موردی است که موادی که باید استریل شوند قرار داده میشوند. اندازه محفظه فشار از 100 لیتر تا 3000 لیتر متغیر است.
درب یا درپوش: درپوش در داخل اتوکلاو شرایط استریل شده ایجاد میکند. درپوش از طریق گیرههای پیچ و واشر آزبست به صورت هوا بسته میشود. درپوش از اجزای مختلف دیگری مانند موارد زیر تشکیل شده است: فشارسنج یک فشارسنج روی درب اتوکلاو وجود دارد تا نشاندهنده فشار ایجاد شده در اتوکلاو در حین استرلیزاسیون باشد. فشارسنج بسیار ضروری است زیرا ایمنی اتوکلاو و شرایط کارکرد عملیات را تضمین میکند.
واحد تخلیه فشار: یک سوت روی درب اتوکلاو همان صدای زودپز است. سوت با آزاد کردن مقدار مشخصی از بخار، فشار داخل محفظه را کنترل میکند.
دریچه اطمینان: یک شیر ایمنی روی درب اتوکلاو وجود دارد که در مواردی که اتوکلاو عملکرد خود را انجام ندهد یا فشار داخل به طور غیرقابل کنترل افزایش یابد بسیار مهم است. این شیر دارای یک لایه لاستیکی نازک است که برای رهایی از فشار و جلوگیری از خطر انفجار خود را منفجر میکند.
مولد بخار: یک ژنراتور بخار الکتریکی یا دیگ بخار در زیر محفظه وجود دارد که از یک سیستم گرمایش الکتریکی برای گرم کردن آب و تولید بخار در محفظه داخلی و خارجی استفاده میکند. سطح آب موجود در محفظه داخلی به گونهای حیاتی است که گویی آب کافی نیست. احتمال سوختن سیستم گرمایش وجود دارد. به طور مشابه، اگر آب بیش از حد لازم باشد، ممکن است با سینیها و سایر اجزای موجود در داخل محفظه تداخل داشته باشد.
مولد خلأ: در برخی از انواع اتوکلاوها، ژنراتور خلأ جداگانهای وجود دارد که هوا را از داخل محفظه بیرون میکشد تا خلا در داخل محفظه ایجاد شود. وجود برخی از حفرههای هوا در داخل محفظه ممکن است از رشد میکروارگانیسمهای مختلف حمایت کند. به همین دلیل است که محفظه خلأ جزء مهمی از اتوکلاو است.
کولر فاضلاب: بسیاری از اتوکلاوها دارای سیستم خنک کننده پساب قبل از ورود به لولههای تخلیه هستند. این سیستم به دلیل ارسال آب جوش از اتوکلاو از هرگونه آسیب به لوله زهکشی جلوگیری میکند.
محیط کشت میکروبی
محیط کشت برای اکثر آزمایشات میکروبیولوژیکی از اهمیت اساسی برخوردار است و برای به دست آوردن محیط کشتهای خالص، برای رشد و شمارش سلولهای میکروبی، و برای پرورش و انتخاب میکروارگانیسمها استفاده میشود. بدون محیط کشتهای با کیفیت بالا، امکان دستیابی به نتایج آزمایش میکروبیولوژیکی دقیق و قابل تکرار کاهش مییابد.
محیط کشت میکروبیولوژیکی دارای موادی است که امکان رشد، حمایت و بقای میکروارگانیسمها را فراهم میکنند. محیط کشت حاوی مواد مغذی، عوامل محرک رشد، منابع انرژی، نمک های بافر، مواد معدنی، فلزات و عوامل ژلزایی (برای محیطهای جامد) است.
میکروبیولوژیستها از قرن نوزدهم از محیط کشتهای محیط کشتی استفاده میکردند. حتی با افزایش استفاده از روشهای سریع، اکثر تکنیکهای موجود در آزمایشگاه کنترل کیفیت دارویی به محیط رشد نیاز دارند. برای ارزیابی محیط کشتهای محیط کشتی، هیچ استاندارد قطعی وجود ندارد. با توجه به این موارد، این مقاله ملاحظاتی را برای طراحی آزمایش و انتخاب و کنترل میکروارگانیسمها ارائه میدهد. روزانه میلیونها آزمایش پزشکی در سراسر جهان انجام میشود. بسیاری از آزمایشات به نمونه خون، ادرار یا سایر مایعات بدن یا حتی بافت نیاز دارند و کشت موفق میکروارگانیسمهای آنها برای بررسی باکتریهای بدن بیمار لازم هستند.
جالب است که رشد باکتریها مانند رشد، به عنوان مثال، رشد یک گیاه نیست. با این حال، بین آنها از نظر نیاز به غذا یا محیط کشت میکروبیولوژیکی شباهت وجود دارد. محیط کشتهای میکروبیولوژیکی یا محیط کشت باکتری، یک محیط رشد است که برای رشد باکتریها استفاده میشود. به عبارت دیگر، حاوی همه چیز است که باکتریها برای رشد در خارج از بدن و در شرایط آزمایشگاهی نیاز دارند.
کشتهای غذایی میکروبی باکتریها، مخمرها یا کپکهای زندهای هستند که در تولید غذا استفاده میشوند. کشتهای غذایی میکروبی فرآیند تخمیر را در مواد غذایی انجام میدهند. مورد استفاده انسان از دوره نوسنگی (حدود 10 هزار سال قبل از میلاد) تخمیر به حفظ غذاهای فاسدشدنی و بهبود ویژگیهای تغذیهای و ارگانولپتیک آنها (در این مورد، طعم، بینایی، بو، لمس) کمک میکند. از سال 1995، غذای تخمیر شده بین یک چهارم تا یک سوم غذای مصرفی در اروپای مرکزی را شامل میشد.
بیش از 260 گونه مختلف محیط کشت غذایی میکروبی برای استفاده مفید آنها در محصولات غذایی تخمیر شده در سطح جهان شناسایی و توصیف شده است که اهمیت استفاده از آنها را نشان میدهد. منطق علمی عملکرد میکروبها در تخمیر با کشفیات لوئیس پاستور در نیمه دوم قرن 19 آغاز شد. مطالعه علمی گسترده همچنان به توصیف محیط کشتهای غذایی میکروبی میپردازد که به طور سنتی در تخمیر مواد از نظر طبقهبندی، فیزیولوژیکی، بیوشیمیایی و ژنتیکی مورد استفاده قرار میگیرند. این امر باعث درک بهتر و بهبود فرآیند غذای سنتی میشود و زمینههای جدیدی را برای کاربرد در صنعت ایجاد میکند.
انواع محیط کشت میکروبی
طیف وسیعی از محیط کشتهای مختلف محیط کشت موجود است. انواع مختلف محیط کشتهای محیط کشتی معمولاً بر اساس وضعیت فیزیکی محیط کشت به موارد زیر تقسیم میشوند: محیط کشت محیط کشت مایع، که معمولاً آبگوشت نامیده میشود محیط کشت جامد و نیمه جامد، که معمولاً آگار نامیده میشود سپس میتوان چنین محیطهایی را به دسته هایی مانند محیطهای رشد (طراحی شده برای رشد بیشتر میکروارگانیسمهای هتروتروف)، محیط کشتهای حمل و نقل (برای حفظ میکروارگانیسمها)، محیطهای غنی کننده (محیط کشتهایی که برای افزایش تعداد میکروارگانیسمهای مورد نظر طراحی شدهاند) و محیطهای رشد انتخابی تقسیم بندی کرد.
آزمایشگاه میکروبیولوژی دارویی بسته به کاربرد مورد نیاز از طیف وسیعی از محیطهای کشت استفاده میکند. دو نوع محیط معمولی رایج عبارتند از آگار یا آبگوشت مغذی، و سوپ آگار یا آبگوشت تریپتون. تریپتون سویا آگار (معادل محیط هضم کازئین سویا)، به ویژه، به طور گسترده ای برای نظارت بر محیط زیست استفاده میشود. از این محیط برای جداسازی و پرورش میکروارگانیسمهای غیر سریع و سریع استفاده میشود. سوپ تریپتون سویا برای آزمایش نازایی و به عنوان آبگوشت رشد عمومی در آزمایشهای شمارش میکروبی و همچنین برای آزمایشهای شبیه سازی محیط کشت استفاده میشود.

در برخی از آزمایشات پرکننده محیط کشت، آب پپتون سبزیجات به عنوان جایگزین استفاده میشود زیرا حاوی هیچ گونه فرآورده حیوانی نیست. سایر انواع محیط کشتهای مورد استفاده شامل محیط مایع تیوگلیکولات است که برای رشد باکتریها (هوازی و بیهوازی) به عنوان بخشی از آزمایش نازایی استفاده میشود. در مواردی که نظارت بر قارچها ضروری است، مانند بخشی از رژیم نظارت بر محیط زیست، محیط کشتهای رایج مورد استفاده عبارتند از سابورود دکستروز آگار یا مالت اضافی آگار. برای بررسی میکروبیولوژیکی آب، R2A استفاده میشود. این یک آگار کم مغذی است که برای کشت میکروارگانیسمهای هتروتروف استفاده میشود.
محیط کشتهای دیگر برای شناسایی میکروبیولوژیکی مانند کلمبیا آگار خون (برای تشخیص واکنش های همولیتیک توسط استافیلوکوکها) استفاده میشوند. تولید محیط کشتها یا در خانه انجام میشود (که در آن از فرمول آبگیری استفاده میشود) یا به طور معمول بصورت آماده خریداری میشود. در مواردی که محیط کشتها آماده استفاده میشوند، میکروبیولوژیست وظیفه ممیزی تولید کننده محیط کشت را بر عهده دارد. برای برخی از محیط کشتهای بشقابی، مانند مواردی که در اتاق های تمیز استفاده میشود، محیط باید با تابش استریل شود.
محیط کشت باکتری
محیط کشت باکتریایی زمانی مورد استفاده قرار میگیرد که یک باکتری خاص باید به منظور تأیید وجود عفونت یا مطالعه بیشتر یک باکتری خاص مورد استفاده قرار گیرد. امروزه هزاران محیط کشت مختلف مورد استفاده قرار میگیرد. محیط کشتهای میکروبیولوژیکی را میتوان در دو دسته اصلی طبقه بندی کرد. شیمیایی یا آلی یک محیط کشت کاملاً شیمیایی از محیط شیمیایی برای تامین مواد مغذی مورد نیاز یک موجود استفاده میکند.
یک محیط آلی حاوی مواد آلی است که ممکن است یک باکتری خاص برای رشد به آن نیاز داشته باشد. علاوه بر این، از محیط کشت باکتریایی میتوان برای رشد انواع مختلف باکتریها استفاده کرد.
از سوی دیگر، محیط کشتهای انتخابی زمانی مورد استفاده قرار میگیرند که فقط یک نوع باکتری خاص باید رشد کند. برای رد این که یک محصول نهایی مانند دارو، دستگاه پزشکی، بافت یا ایمپلنت آلوده به میکروارگانیسمها باشد، از محیط کشت باکتریایی استفاده میشود. این محیط کشت میکروبیولوژیست را قادر میسازد تا هر ارگانیسم را شناسایی و اندازهگیری کند تا ایمنی بیمار تضمین شود.
با استفاده از محیط کشت باکتریایی است که وجود عفونت باکتریایی یا تایید میشود یا نه. اگرچه روشهای دیگری برای انجام این کار وجود دارد، اما رشد میکروبها دقیق ترین روش است. به عبارت ساده، مگر اینکه محیط کشتهای میکروبیولوژیکی وجود داشته باشند، تأیید دقیق بیماری بسیار دشوار است. چه برای شناسایی باکتریها برای استفاده تجاری و چه برای شناسایی و تأیید عفونت ها، دانستن اطلاعات اولیه در مورد محیطهای میکروبی برای درک آن بسیار مهم است.
ویژگیهای میکروبیولوژیکی آزمایش عقیم بودن محیط برای تشخیص آلودگی میکروبی در طول فرایند تولید طراحی شده است. در اینجا تعداد کمی، به طور معمول از دسته، از کالاهای بدون تلقیح انکوبه میشوند. دما و زمان انتخاب شده برای انکوباسیون آزمایش عقیم بودن به نوع محیط بستگی دارد. برای محیط کشتهای عمومی، دمای 30 تا 35 درجه سانتیگراد به مدت سه روز معمول است. برای تایید آزمون استریل بودن نباید رشد نشان دهند. مسلماً چالش محیط کشت با میکروارگانیسمها مهمترین آزمایشی است که در آزمایشگاه میکروبیولوژی انجام شده است. اینکه چنین آزمایش کلیدی توسط سازنده محیط کشت انجام میشود، بدون تردید است.

علاوه بر این، کاربر باید ارتقای رشد را انجام دهد، تنوع دسته به دسته را بررسی کند یا هرگونه مشکلی را هنگام حمل و نقل ارزیابی کند. برای ارتقای رشد، به یک پانل از میکروارگانیسمها نیاز است تا مناسب بودن محیط کشت را برای استفاده موردنظر خود نشان دهند. فارماکوپه میکروارگانیسمهای خاصی را توصیه میکند و اینها باید در یک مجموعه کشت معتبر مانند مجموعه محیط کشت آمریکایی نوع (ATCC) قابل ردیابی باشند (اگرچه فارماکوپه اجازه میدهد تا از مجموعههای کشت جایگزین استفاده شود، ابهاماتی در مورد معادل سازی سویه وجود دارد). محیط کشتهای نوع باید با دقت در مجموعه محیط کشت آزمایشگاه نگهداری شوند. این شامل اطمینان از حفظ محیط کشت در دمای پایین به اندازه کافی برای جلوگیری از وقوع تغییرات فنوتیپی و محدود کردن تعداد گذرگاه ها بین مراحل خرده محیط کشت به کمتر از پنج است.
علاوه بر محیط کشتهای نوع، جدا شده های محیطی معمولاً در رژیم های آزمایش محیط کشت استفاده میشود. این موجودات به گونهای طراحی شدهاند که نشان دهند بسیاری از محیطهای کشت میکروارگانیسمهایی را پرورش میدهند که نمایانگر انواع موجود در محیط تولید هستند. بنابراین محیط کشتهایی که برای بررسی آب مورد استفاده قرار می گیرند دارای یک صفحه آزمایش هستند که شامل جدا شدههای میکروبی از آب (مانند باکتریهای مرتبط با سودوموناد) و محیطهای مورد استفاده برای نظارت بر محیط شامل باکتریهای گذرا به پوست انسان (مانند استافیلوکوکها) است.
در حالی که استفاده از چنین جدایه ها به طور فزایندهای به یک انتظار نظارتی تبدیل شده است، پذیرش جدایههای محیطی یا گیاهی توسط همه میکروبیولوژیستها پشتیبانی نمیشود. استدلال برای استفاده از چنین جدایهها این است که محیط کشتها با آن میکروارگانیسمهایی که در محیط داروسازی واقع شدهاند به چالش کشیده میشوند و اینها اغلب بیشتر از محیط کشتهای استاندارد هستند. علاوه بر این، باکتریهای جدا شده میتوانند در طول زمان، بر اساس بررسیهای مربوط به میکرو فلورا، متفاوت باشند.
ارزیابیهای بین آزمایشگاهی مشکل هستند زیرا هر آزمایشگاه از مجموعه ارگانیسمها و روشهای کالیبره شده متفاوتی استفاده میکند. نکته دوم این است که هنگامی که موجودات زنده روی محیط استاندارد رشد میکنند، از سایر سویه های آزمایشگاهی قابل تشخیص نیستند. برعکس گفته شده است که جدا شده های محیطی با حداقل خرده محیط کشت دارای جنبه هایی از ویژگیهای نوع وحشی خود هستند. نتیجه این بحث ادامه دارد و به وضوح به مطالعات بیشتری نیاز است. سطح عددی چالش میکروبی یکی دیگر از ملاحظات مهم است. اکثر رژیمهای آزمایشی نیاز به یک چالش سطح پایین دارند. این نشان میدهد که محیط کشتها میتوانند تعداد کمی از میکروارگانیسمها را بازیابی کنند.
محیط کشت جامد
روشهای کیفی و کمی مختلفی وجود دارد که میتوان برای رژیم آزمایش در نظر گرفت. برای آزمایش آگار، رویکردهای کیفی شامل رگه های زیر کشت ساده (صفحات گسترده) است. در اینجا، محیط کشتهای مایع با حلقهای از تلقیح ردیف شدهاند تا کلونیها واحد ایجاد شود. سپس میتوان هر بخش از صفحه آگار را با ویژگی های رشد یک صفحه کنترل مناسب مقایسه کرد (یک محیط کنترل دسته ای از محیط آزاد شده است که قبلاً دارای خواص ارتقاء رشد خوب ارزیابی شده بود). سیستم قوی تری از طریق تکنیکهای کمی تضمین میشود. اینها به طور کلی به دو گروه تقسیم میشوند: اقتصادسنجی و مایلز میسرا.
هر دو این آزمایشها یک مجموعه محیط کشت (یک دسته قبلاً منتشر شده) را با دیگری (دسته مورد آزمایش) مقایسه میکنند. روش اقتصادسنجی یک نوع نیمه کمی از روش خط خوردگی است. یک حلقه تلقیح روی صفحه قرار داده میشود و به صورت متوالی رگه را به نوار رقیق میکند. پنج رگه به صورت چهار ربع روی صفحه آگار به همراه یک رگه آخر در مرکز صفحه پهن شده است. رشد باید در همه رگهها رخ دهد. تکنیک مایلز-میسرا (روش شمارش قطره) شامل پخش قطرات مقدار معلق سوسپانسیون میکروبی (معمولاً 10 میکرولیتر) است. بعد از انکوباسیون، صفحه آزمایش از نظر تعداد کلونیها بازیابی شده با یک صفحه کنترل مقایسه میشود.
دقت روش بستگی به رقت استفاده شده، تعداد واحدهای تشکیلدهنده کلونی در تلقیح، حجم تلقیح های مورد استفاده و تکنیک پخش دارد. نتیجه معمولاً زمانی به عنوان نسبت بهرهوری بیان میشود که، پس از انکوباسیون، تعداد دستهای از مواد آزاد شده قبلی به تعداد محیط آزمایش تقسیم شود. نسبت بهرهوری قابل قبول باید برابر یا بیشتر از 0/5 و با حد بالای 2 باشد (این معادل بازیابی 50 تا 200 است).

محیط کشت براث
در مورد محتویات آبگوشت (مایع) ارزیابی کمی آسان نیست. بسیاری از آزمایشگاهها محیط تخم مرغ را با تعداد تخمینی میکروارگانیسمها به چالش میکشند و رشد را در طول زمان با یک گروه کنترل (که ارزیابی کیفی رشد فراوان را ارائه میدهد) مقایسه میکنند. این چالش معمولاً < 100 cfu است و زمان دستیابی به رشد بین سه تا پنج روز است. سپس رشد بین گروه آزمایشی و گروه کنترل با الزامی که هر دو باید رشد فراوان را نشان دهند، مقایسه میشود. متناوباً، برخی از آزمایشگاهها با ساختن شاخص رشد از رشد اندک تا رشد فراوان (به طور معمول مقیاس +، ++ یا +++) رویکردی نیمه کمی را امتحان میکنند.
یکی از روشهای کشت باکتریایی کشت مایع است که در آن باکتریهای مورد نظر در یک محیط مایع مغذی مانند Luria Broth در یک فلاسک عمودی معلق میشوند. این به یک دانشمند اجازه میدهد تا مقادیر زیادی باکتری را برای انواع برنامههای پایین دستی پرورش دهد. کشت مایع برای تهیه یک روش ضد میکروبی ایدهآل است که در آن آزمایشگر آب مایع را با باکتری تلقیح میکند و اجازه میدهد تا یک شبه رشد کند (ممکن است از شیکر برای رشد یکنواخت استفاده کنند). سپس نمونههایی از نمونه را برای آزمایش فعالیت ضد میکروبی یک دارو یا پروتئین خاص (پپتیدهای ضد میکروبی) میگیرند. به عنوان جایگزین، میکروبیولوژیست ممکن است تصمیم بگیرد از کشتهای مایع استاتیک استفاده کند. این محیط کشتها تکان داده نمیشوند و شیب اکسیژن را برای میکروبها فراهم میکنند.
محیط کشت آگار
محیط کشتهای میکروبیولوژیکی را میتوان در ظروف پتری با اندازههای مختلف که دارای لایه نازکی از محیط رشد بر پایه آگار هستند، کشت کرد. هنگامی که محیط رشد در پتری دیش با باکتریهای مورد نظر تلقیح شد، صفحات در دمای مطلوب برای رشد باکتریهای منتخب (به عنوان مثال، معمولاً در دمای 37 درجه سانتیگراد یا دمای بدن انسان، برای کشت از انسان ها انکوبه میشوند. یا حیوانات، یا کمتر برای محیط کشتهای محیطی). پس از دستیابی به سطح مطلوب رشد، صفحات آگار را میتوان برای مدت طولانی در یخچال وارونه نگه داشت تا باکتریها برای آزمایشات بعدی نگهداری شوند.
انواع افزودنیها وجود دارد که میتوان قبل از ریختن آگار در صفحه و اجازه جامد شدن به آن افزود. برخی از انواع باکتریها تنها در حضور برخی افزودنیها میتوانند رشد کنند که میتواند هنگام ایجاد گونههای مهندسی شده باکتریها که حاوی ژن مقاوم در برابر آنتیبیوتیکها هستند نیز استفاده شود. هنگامی که آنتیبیوتیک انتخاب شده به آگار اضافه میشود، تنها سلولهای باکتریایی حاوی ژن مقاومکننده قادر به رشد هستند. این به محقق اجازه میدهد تنها کلونیها را که با موفقیت تغییر شکل دادهاند انتخاب کند.
(Agar based dipsticks) نسخه مینیاتوری شده صفحات آگار است که برای قالب های چسب استفاده میشود، به عنوان مثال. دیپ اسلاید، دیپستیک دیجیتال پتانسیل استفاده از آنها را در محل مراقبت برای اهداف تشخیص نشان میدهد. آنها مزایایی نسبت به صفحات آگار دارند زیرا مقرون به صرفه هستند و عملکرد آنها نیازی به تخصص یا محیط آزمایشگاهی ندارد که میتواند از آنها در محل مراقبت استفاده شود.
محیط کشت جامد عمودی
مشابه صفحات آگار هستند اما توسط آگار جامد در یک لوله آزمایش تشکیل میشوند و در لوله به صورت عمودی قرار دارند. باکتریها از طریق سوزن تلقیح یا نوک پیپت که به مرکز آگار استب زده میشود معرفی میشوند. باکتریها در ناحیه سوراخ شده رشد میکنند. محیط کشتهای استب اغلب برای ذخیرهسازی کوتاه مدت یا حمل و نقل محیط کشتها استفاده میشود.
روش شمارش باکتری
روشهای مختلفی برای شمارش باکتریها وجود دارد که عبارتند از:
- رقیقسازی سریالی: رقیقسازی سریالی (یا رقت لاگ) فرایندی است که برای کاهش غلظت باکتری به غلظت مورد نیاز برای انجام یک روش آزمایشی خاص انجام میشود. این امر آزمایش را ساده کرده یا غلظت آن را در مورد آبکاری آگار آسانتر میکند.
- شمارش صفحات: نتیجه روش شمارش صفحات نشاندهنده تعداد کلونیهای میکروبی است که تحت شرایط فیزیکی و شیمیایی معین مانند pH، دما، مواد مغذی موجود، وجود ترکیبات بازدارنده رشد قادر به ظهور هستند.
- محتملترین عدد: تکنیک MPN روشی است که برای برآورد غلظت میکروارگانیسمهای زنده در خاک، آب، غذا یا نمونه محصولات کشاورزی مورد استفاده قرار میگیرد. این امر با استفاده از تکرار رشد آبگوشت مایع در رقتهای ده برابر انجام میشود.
- استفاده از اسپکتروفتومتر: در آزمایشگاه میکروبیولوژی، یک اسپکتروفتومتر به طور معمول در طول مطالعات رشد باکتریها مورد استفاده قرار میگیرد تا رشد باکتریها را در زمان معینی در محیط کشت تخمین بزند.
کشت ویروس و فاژ
کشت ویروس یا فاژ به سلولهای میزبان نیاز دارد که در آنها ویروس یا فاژ تکثیر میشوند. برای باکتریوفاژها، کشت با آلوده کردن سلولهای باکتریایی انجام میشود. سپس میتوان فاژ را از پلاکهای ایجاد شده در چمن باکتری روی یک صفحه جدا کرد. کشت ویروس از سلولهای میزبان یوکاریوتی مناسب آنها به دست میآید. روش صفحه خطی راهی برای جداسازی فیزیکی جمعیت میکروبی است و با پخش تلقیح به جلو و عقب با حلقه تلقیح بر روی صفحه آگار جامد انجام میشود. پس از انکوباسیون، کلونیها به وجود میآیند و سلولهای منفرد از زیست توده جدا میشوند. هنگامی که یک میکروارگانیسم در محیط کشت خالص جدا شد، لازم است که آن را برای مطالعه و استفاده بیشتر در وضعیت مناسب حفظ کرد. محیط کشتهای ذخیره باید به گونهای حفظ شوند که هیچگونه ویژگیهای بیولوژیکی، ایمونولوژیکی و محیط کشت آنها از بین نرود.
کشت ویروسی یک تکنیک آزمایشگاهی است که در آن نمونههایی از ویروس در ردههای سلولی مختلف قرار میگیرد که ویروس در حال آزمایش است تا بتواند آن را آلوده کند. اگر سلولها تغییراتی را نشان دهند که تحت عنوان اثرات سیتوپاتیک شناخته میشوند، کشت مثبت است. محیط کشت ویروسی سنتی به طور کلی با کشت ویال پوسته جایگزین شده است، که در آن نمونه روی یک لایه از سلول سانتریفیوژ میشود و رشد ویروس با روشهای تشخیص آنتی ژن اندازهگیری میشود. این امر زمان تشخیص ویروسهای کند رشد مانند سیتومگالوویروس را که این روش برای آنها توسعه یافته است، تا حد زیادی کاهش میدهد.
علاوه بر این، مرحله سانتریفیوژ در کشت ویال پوسته حساسیت این روش را افزایش میدهد زیرا پس از سانتریفیوژ، ذرات ویروسی نمونه در مجاورت سلولها قرار دارند. سلولهای انسان و میمون در محیط کشت سنتی ویروسی و کشت ویال پوسته استفاده میشود. انواع ویروسهای انسانی که با کشت ویروسی قابل شناسایی هستند عبارتند از: آدنوویروس، سیتومگالوویروس، انتروویروسها، ویروس هرپس سیمپلکس، ویروس آنفلوانزا، ویروس پاراآنفلوانزا، رینوویروس، ویروس سینسیتیال تنفسی، ویروس واریسلا زوستر، سرخک و اوریون. برای این موارد، روش شناسایی نهایی عموماً با ایمونوفلورسانس انجام میشود، به استثنای سیتومگالوویروس و رینوویروس، که شناسایی آنها در کشت ویروسی با اثرات سیتوپاتیک تعیین میشود.

محیط کشت قارچ
مستقیمترین و معمولاً قطعیترین روش برای تشخیص تشخیص عفونت قارچی، رشد قارچ از نمونه بیمار است. نمونههای مختلف متعدد میتوانند قارچ ایجاد کنند، از جمله خون، مایع مغزی نخاعی، چرک، ادرار، بافت، نمونههای تنفسی (خلط، شستشوی برونکوسکوپی)، مایع پلور، پریکارد یا صفاقی، تراشیدن پوست، مو، برش ناخن، نمونههای دهانی یا واژینال. پردازش این نمونهها ممکن است شامل سانتریفیوژ یا نرم شدن/ مایع شدن باشد تا بتوان نمونه را روی محیط آگار پخش کرد. تعدادی کتابچه راهنمای آزمایشگاهی و روشهای خاصی برای انجام این کار توصیف شده است، اگرچه مطالعات مقایسهای کمی در مقایسه یک روش با روش دیگر انجام شده است.
عملکرد اکثر قارچها با کشت مستقیم نمونه ها در اصطلاح محیط قارچی بهبود مییابد. برای برخی از قارچها، محیط کشتها همیشه یا تقریباً همیشه بر روی محیط باکتریایی منفی هستند، نمونههایی از آنها هیستوپلاسما (Histoplasma)، سنجاقیکپکسانان (Mucorales) و کوکسیدیوئیدها (Coccidioides spp) هستند. محیط کشت افشانکچه یا آسپرژیلوس (Aspergillus spp). در محیطهای باکتریایی 30 کمتر از محیطهای قارچی موثر است. محیط کشتهای عمومی که معمولاً برای کشت قارچ استفاده میشوند عبارتند از سابورو دکستروز (Sabouraud Dextrose) و عصاره مالت. برای جلوگیری از آلودگی محیط توسط باکتریها، از کلرامفنیکل استفاده میشود، اما از رشد اکتینومیسس (Actinomyces)، که به خوبی در محیط SDA یا سابورو دکستروز آگار (Sabouraud Dextrose Agar) رشد میکنند، جلوگیری میکند. برای کاهش فراوانی رشد قارچهای محیطی، سیکلوهگزیمید اضافه میشود، اما باعث کاهش عملکرد بسیاری از قارچهای فرصت طلب از جمله آسپراژیلوس (Aspergillus spp)، کریپتوکوکوس نئوفورمانس (Cryptococcus neoformans) و گونههای سنجاقیکپکسانان میشود. بنابراین در صورت استفاده از سیکلوهگزیمید، از یک صفحه آگار که حاوی آن نیست نیز باید به طور موازی استفاده شود.
کشت مخمر و یوکاریوت ها
برای یوکاریوتهای تک سلولی مانند مخمر، در جداسازی محیط کشتهای خالص از تکنیکهای مشابه برای کشتهای باکتریایی استفاده میشود. محیط کشتهای خالص موجودات چند سلولی اغلب به سادگی با انتخاب یک فرد واحد برای شروع محیط کشت جدا میشوند. این یک روش مفید برای کشت خالص قارچها، جلبکهای چند سلولی و متازوآهای کوچک است. توسعه تکنیکهای محیط کشت خالص برای مشاهده نمونه مورد نظر بسیار مهم است. متداولترین روش برای جداسازی تک تک سلولها و تولید یک محیط کشت خالص، تهیه یک صفحه خطی است.
روش صفحه خطی راهی برای جداسازی فیزیکی جمعیت میکروبی است و با پخش تلقیح به جلو و عقب با حلقه تلقیح بر روی صفحه آگار جامد انجام میشود. پس از انکوباسیون، کلونیها به وجود میآیند و سلولهای منفرد از زیستتوده جدا میشوند. هنگامی که یک میکروارگانیسم در محیط کشت خالص جدا شد، لازم است که آن را برای مطالعه و استفاده بیشتر در وضعیت مناسب حفظ کرد. محیط کشتهای ذخیره باید به گونهای حفظ شوند که هیچ گونه ویژگیهای بیولوژیکی، ایمونولوژیکی و محیط کشتی آنها از بین نرود.

رقیق کردن نمونه در آزمایشگاه میکروبیولوژی
برای شمارش به باکتری کمتری نیاز است و در حالت ایدهآل فقط باید بین 30 تا 300 باکتری را شمارش کرد که حداکثر چند دقیقه طول میکشد. اگر مقدار کوچکتر و دقیقی از مایع کشت را بیرون بیاورید، میتوان باکتریها را شمارش کرد و بر اساس نسبت آن به کل محیط کشت، تعداد باکتریهای موجود در نمونه اولیه را تعیین کرد.
اما میلیاردها سلول باکتری وجود دارند که برای توانایی شمارش آنها باید به 30 تا 300 رسید. برای انجام این کار، باید نمونه را حدود 10 میلیون برابر رقیق کرد. حدود 15 میلیلیتر از نمونه را (حدود 3 قاشق چای خوری) بردارید و آن را در رقیق کنید. میتوان یکبار رقیقسازی را انجام داد یا با رقیقسازی متوالی، به غلظت مناسب سلولها رسید.
به این روش رقیقسازی سریالی میگویند. مجموعهای از رقتهای متوالی برای کاهش تراکم سلولها در محیط کشت به میزان غلظت قابل استفاده تهیه میشوند. هر رقیق سازی غلظت باکتریها را به میزان مشخص کاهش میدهد. بنابراین با محاسبه رقت کل میتوان فهمید که تعداد کل باکتریها چقدر است. رقت متوالی رقیق شدن مرحلهای یک ماده در محلول است. معمولاً ضریب رقت در هر مرحله ثابت است و منجر به پیشرفت هندسی غلظت به صورت لگاریتمی میشود. رقتهای سریالی برای ایجاد محلولهای بسیار رقیق و همچنین محلولهایی برای آزمایشهایی که منجر به منحنی غلظت با مقیاس لگاریتمی میشود، استفاده میشود.
رقت ده برابر برای هر مرحله رقت لگاریتمی، رقت 3/16 برابر (100/5 برابر) رقیق سازی نیمه لگاریتمی یا رقت نیم لاگ و رقت 1/78 برابر (100/25 برابر) نامیده میشود. رقت یک چهارم لگاریتمی یا رقت یک چهارم لاگ نامیده میشود. رقیقسازیهای سری به طور گستردهای در علوم تجربی از جمله بیوشیمی، داروسازی، میکروبیولوژی و فیزیک مورد استفاده قرار میگیرند.
رنگآمیزی گرم چیست؟
رنگآمیزی گرم یا رنگآمیزی گرم، که روش گرم نیز نامیده میشود، روش رنگآمیزی است که برای تمایز و طبقهبندی باکتریهای گرم مثبت و باکتریهای گرم منفی استفاده میشود. این نام از باکتری شناس دانمارکی هانس کریستین گرم گرفته شده است که این تکنیک را توسعه داده است. رنگآمیزی گرم باکتریها را از نظر ویژگیهای شیمیایی و فیزیکی دیواره سلولی متمایز میکند. باکتریهای گرم مثبت دارای یک لایه ضخیم از پپتیدوگلیکان در دیواره سلولی هستند که رنگ اولیه یعنی بنفش کریستالی را حفظ میکند.
سلولهای گرم منفی دارای لایه نازکتری از پپتیدوگلیکان هستند که اجازه میدهد بنفش کریستالی با افزودن اتانول شسته شود. آنها توسط ضد رنگ، معمولاً سافرانین یا فوکسین، صورتی یا قرمز رنگ میشوند. محلول ید لوگول همیشه پس از افزودن بنفش کریستالی برای تقویت پیوندهای رنگ با غشای سلولی اضافه میشود. رنگآمیزی گرم تقریباً اولین قدم در شناسایی اولیه یک ارگانیسم باکتریایی است. در حالی که رنگآمیزی گرم یک ابزار تشخیصی ارزشمند در هر دو زمینه بالینی و تحقیقاتی است، نمیتوان همه باکتریها را به طور قطعی با این روش طبقهبندی کرد. این باعث ایجاد گروههای متغیر گرم و گرم نامعین میشود.
رنگآمیزی گرم یک روش آزمایشگاهی باکتریولوژیکی است که برای تمایز گونههای باکتریایی به دو گروه بزرگ (گرم مثبت و گرم منفی) بر اساس خواص فیزیکی دیوارههای سلولی آنها استفاده میشود. رنگآمیزی گرم استفاده نمیشود برای طبقهبندی آرکیباکترها، از آنجایی که این میکروارگانیسمها واکنشهای متفاوتی را ارائه میدهند که از گروه فیلوژنتیک آنها پیروی نمیکند. برخی از موجودات گرم متغیر هستند (به این معنی که ممکن است رنگ منفی یا مثبت داشته باشند). برخی از آنها با هر دو رنگ مورد استفاده در تکنیک گرم رنگآمیزی نشدهاند و دیده نمیشوند.
در آزمایشگاه مدرن میکروبیولوژی محیطی یا مولکولی، بیشتر شناسایی با استفاده از توالیهای ژنتیکی و سایر تکنیکهای مولکولی انجام میشود، که بسیار خاصتر و آموزندهتر از رنگآمیزی متفاوت است. پیشنهاد شده است که رنگآمیزی گرم به عنوان یک روش تشخیصی مؤثر در روش PCR در یک گزارش اولیه تحقیق در مورد سوزاک مفید باشد. در صورت مشکوک بودن به عفونت، رنگآمیزی گرم روی مایعات ترشحی یا بیوپسی شده انجام میشود. رنگآمیزی گرم بسیار سریعتر از کشت نتیجه میدهند و به ویژه زمانی اهمیت دارد که عفونت تفاوت مهمی در درمان و پیش آگهی بیمار ایجاد کند. نمونهها شامل مایع مغزی نخاعی برای مننژیت و مایع مفصلی برای آرتریت سپتیک هستند.

باکتریهای گرم مثبت دارای دیواره سلولی ضخیمی از پپتیدوگلیکان (50 تا 90 درصد از پوشش سلولی) هستند و در نتیجه بنفش کریستالی به رنگ بنفش رنگآمیزی میکند، در حالی که باکتریهای گرم منفی یک لایه نازکتر (10 از سلول) دارند. پاکت)، بنابراین رنگ بنفش را حفظ نکنید و توسط سافرانین صورتی ضد رنگ شده است. چهار مرحله اساسی برای رنگآمیزی گرم وجود دارد:
- استفاده از رنگ اولیه (بنفش کریستالی) بر روی اسمیر ثابت شده با حرارت از یک کشت باکتریایی. تثبیت حرارتی برخی از باکتریها را از بین میبرد اما بیشتر برای چسباندن باکتریها به لغزش استفاده میشود تا در طول روش رنگآمیزی آنها شسته نشوند.
- افزودن ید که به بنفش کریستال متصل شده و آن را در سلول به دام میاندازد.
- رنگزدایی سریع با اتانول یا استون
- ضد رنگ با سافرانین. گاهی کاربول فوکسین جایگزین سافرانین میشود، زیرا باکتریهای بیهوازی را قویتر رنگآمیزی میکنند، اما کمتر به عنوان ضد رنگ استفاده میشود.
بنفش کریستالی (CV) در محلولهای آبی به CV+ تجزیه میشود و کلرید (Cl−) یونها این یونها به دیواره سلولی سلولهای گرم مثبت و گرم منفی نفوذ میکنند. CV+ یون با اجزای دارای بار منفی سلولهای باکتری در تعامل است و سلولها را بنفش رنگ میکند.
یدید (۱- یا 3-) با CV+ تعامل دارد و مجموعههای بزرگی از بنفش کریستالی و ید (CV -I) را در لایههای داخلی و خارجی سلول تشکیل میدهد. ید غالباً به عنوان یک ماده غلیظ نامیده میشود، اما یک عامل به دام انداختن است که از حذف کمپلکس CV -I جلوگیری میکند و بنابراین سلول را رنگ میکند. هنگامی که یک رنگ کننده مانند الکل یا استون اضافه میشود، با لیپیدهای غشای سلولی تداخل میکند. یک سلول گرم منفی غشای لیپوپلی ساکارید خارجی خود را از دست میدهد و لایه داخلی پپتیدوگلیکان در معرض دید قرار میگیرد. مجتمعهای CV-I همراه با غشای خارجی از سلول گرم منفی شسته میشوند.
در مقابل، یک سلول گرم مثبت در اثر درمان با اتانول دچار کم آبی میشود. مجتمع های بزرگ CV-I به دلیل ماهیت چند لایه پپتیدوگلیکان در سلول گرم مثبت محبوس میشوند. مرحله رنگ زدایی بسیار مهم است و باید به درستی زمانبندی شود. اگر عامل رنگزا بیش از حد (در عرض چند ثانیه) باقی بماند، رنگ بنفش کریستالی از سلولهای گرم مثبت و منفی حذف میشود. پس از رنگزدایی، سلول گرم مثبت بنفش و سلول گرم منفی رنگ بنفش خود را از دست میدهد. ضد رنگ که معمولاً دارای بار مثبت سافرانین یا فوکسین پایه است، آخرین بار مورد استفاده قرار میگیرد تا رنگ باکتریهای گرم منفی رنگ شده را صورتی یا قرمز نشان دهد. هم باکتریهای گرم مثبت و هم باکتریهای گرم منفی ضد رنگ را جمع میکنند. با این حال، ضد رنگ روی باکتریهای گرم مثبت به دلیل رنگ تیرهتر بنفش کریستالی دیده نمیشود. مواد لازم برای رنگآمیزی گرم عبارتند از:
- بنفش کریستالی (رنگ اولیه)
- محلول ید/ید گرم (غلیظی که بنفش کریستالی را به دیواره سلولی ثابت میکند)
- رنگ زدا (به عنوان مثال اتانول)
- سافرانین (رنگ ثانویه)
- آب (ترجیحا در یک بطری اسپورت)

این رنگآمیزی شامل مراحل زیر است:
- یک اسلاید از نمونه سلول تهیه کنید تا رنگآمیزی شود. با گرم کردن اسلاید با قطره یا قطعه کوچکی از نمونه از روی مشعل Bunsen، سه بار نمونه را روی اسلاید قرار دهید.
- رنگ اولیه (بنفش کریستالی) را به نمونه یا اسلاید اضافه کرده و به مدت 1 دقیقه انکوبه کنید. اسلاید را با جریان ملایم آب به مدت حداکثر 5 ثانیه شستشو دهید تا بنفش کریستالی بدون محدودیت خارج شود.
- ید گرم را به مدت 1 دقیقه اضافه کنید. این یک ماده غلیظ است یا عاملی است که بنفش کریستالی را به دیواره سلولی باکتری ثابت میکند.
- نمونه/ اسلاید را با استون یا الکل به مدت 3 ثانیه بشویید و با جریان ملایم آب بشویید. اگر الکل گرم منفی باشد، رنگ بنفش کریستالی را از بین میبرد. با این حال، اگر الکل برای مدت طولانی روی نمونه باقی بماند، ممکن است باعث تغییر رنگ سلولهای گرم مثبت نیز شود.
- رنگ ثانویه، سافرانین را به اسلاید اضافه کرده و به مدت 1 دقیقه انکوبه کنید. با جریان ملایم آب حداکثر 5 ثانیه بشویید. اگر باکتریها گرم مثبت باشند، رنگ اصلی (بنفش کریستالی) را حفظ میکند و رنگ ثانویه (سافرانین) را نمیگیرد و باعث میشود زیر میکروسکوپ بنفش/بنفش به نظر برسد. اگر باکتری گرم منفی باشد، رنگ اولیه را از دست میدهد و رنگ ثانویه را میگیرد و در صورت مشاهده زیر میکروسکوپ قرمز میشود.
رنگ آمیزی کپسول
هدف اصلی رنگآمیزی کپسول تشخیص مواد کپسولی از سلول باکتری است. کپسول یک لایه خارجی ژلاتینی است که توسط سلول باکتریایی ترشح میشود و دیواره سلولی را احاطه کرده و به آن میچسبد. اکثر کپسولها از پلیساکاریدها تشکیل شدهاند اما برخی از آنها از پلیپپتیدها تشکیل شدهاند. این کپسول با لایه لجن که اکثر سلولهای باکتریایی تولید میکنند متفاوت است زیرا یک لایه ضخیم، قابل تشخیص و گسسته در خارج از دیواره سلولی است. رنگآمیزی کپسول از یک رنگآمیزی اسیدی و یک رنگآمیزی اساسی برای تشخیص تولید کپسول استفاده میکند. ترکیبات و مواد لازم برای رنگآمیزی کپسول عبارتند از:
- بنفش کریستالی (1٪) بنفش کریستال (85٪ رنگ) = 1 گرم آب مقطر = 100 میلی لیتر
- نیگروسین نیکروزین محلول در آب = 10 گرم آب مقطر = 100 میلی لیتر
کپسولها با معرفهایی که در رنگآمیزی ساده استفاده میشوند بسیار ضعیف رنگ میگیرند و رنگ کپسول بسته به روش ممکن است نام اشتباه باشد زیرا ممکن است کپسول رنگآمیزی شود یا نشود. روشهای رنگآمیزی منفی، زمینهای شفاف، رنگ تیره با سلولهای رنگآمیزی شده اما کپسول بدون رنگ را در تضاد قرار میدهد. زمینه با جوهر هند یا نیگروسین یا قرمز کونگو شکل میگیرد. جوهر هند امروزه به سختی به دست میآید. با این حال، نیگروسین به راحتی به دست میآید. رنگ کپسول مثبت نیاز به رنگی دارد که کپسول را رسوب میکند. با رنگآمیزی با رنگهایی مانند بنفش کریستالی یا متیلن بلو، دیواره سلولی باکتری رنگ را میگیرد.
کپسولها با سلولهای رنگآمیزی شده در پس زمینه تیره بیرنگ به نظر میرسند. کپسولها شکننده هستند و با گرم شدن میتوان آنها را کاهش، خشک، مخدوش یا از بین برد. برای افزایش اندازه کپسول و مشاهده آسانتر آن با یک میکروسکوپ نوری ترکیبی معمولی، میتوان از یک قطره سرم در طول اسمیر استفاده کرد.

رنگ آمیزی اسید فاست چیست؟
این تکنیک نوعی رنگآمیزی افتراقی است که ابتدا توسط Ziehl توسعه داده شد و بعدا توسط Neelsen اصلاح شد. بنابراین این روش را رنگآمیزی Ziehl-Neelsen نیز مینامند. نیلسن در سال 1883 از کربول فوکسین و حرارت Ziehl استفاده کرد و سپس با یک الکل اسیدی رنگ زد و با رنگ متیلن رنگآمیزی کرد. بنابراین تکنیکهای رنگآمیزی Ziehl-Neelsen توسعه داده شد.
هدف اصلی این رنگآمیزی تمایز باکتریها به دو گروه اسید فست و سریع سریع غیر اسیدی است. این روش برای آن دسته از میکروارگانیسمهایی استفاده میشود که با روش رنگآمیزی ساده یا گرم رنگآمیزی نمیشوند، به ویژه اعضای جنس مایکوباکتریوم، مقاوم هستند و تنها با رنگآمیزی اسید فست قابل مشاهده هستند.
هنگامی که اسمیر با کاربول فوکسین رنگآمیزی میشود، مواد لیپوئیدی موجود در دیواره سلولی مایکوباکتریوم را حل میکند اما با استفاده از گرما، کربوکس فوکسین بیشتر از طریق دیواره لیپوئیدی نفوذ کرده و وارد سیتوپلاسم شده و سپس تمام سلول قرمز میشود. سپس اسمیر با عامل رنگزدا (3٪ HCL در 95٪ الکل) رنگآمیزی میشود اما سلولهای اسید فست به دلیل وجود مقدار زیادی مواد لیپوئیدی در دیواره سلولی آنها که مانع نفوذ محلول رنگزدایی میشوند، مقاوم هستند. ارگانیسمهای سریع غیر اسیدی فاقد مواد لیپوئیدی در دیواره سلولی خود هستند و به همین دلیل به راحتی رنگ میشوند و سلولها بیرنگ میشوند. اسمیر را با رنگ ضد رنگ، متیلن بلو رنگآمیزی میکنند. فقط سلولهای رنگ شده رنگ شمارنده را جذب کرده و رنگ آن را میگیرند و آبی به نظر میرسد در حالی که سلولهای اسید فست رنگ قرمز را حفظ میکنند.

رنگ آمیزی اسپور
رنگ آمیزی آندوسپور یک روش رنگ آمیزی افتراقی است که به صورت انتخابی اسپورها را رنگ آمیزی میکند و آنها را از قسمت رویشی سلولها متمایز میکند. اندوسپورها توسط چند جنس باسیل گرم مثبت مانند باسیلوس و کلستریدیوم در پاسخ به شرایط نامساعد محیطی تولید میشوند. اندوسپورها در برابر شرایط محیطی مانند گرما، مواد شیمیایی (همچنین رنگها) بسیار مقاوم هستند و بنابراین نیاز به تکنیکهای خاصی برای رنگ آمیزی دارند. روشهای مختلفی برای رنگ آمیزی اندوسپورها وجود دارد که رایج ترین آنها عبارتند از:
- تکنیک رنگ آمیزی شفر-فولتون
- روشهای دورنر
- روش Zeihl-Nelson اصلاح شده
- روش بارتلومو-میتوار
- روش ابوت
- تکنیک رنگ مولر
به طور کلی میتوان اسپورها را روی رنگهای گرم تشخیص داد (اندوسپورها رنگ دار نمیشوند و به صورت اجسام شکننده و بدون رنگ ظاهر میشوند). اندوسپورها را میتوان در فیلمهای مرطوب بدون رنگ زیر میکروسکوپ کنتراست فاز نشان داد. آنها به صورت اجسام بیضی شکسته یا کروی بزرگ در درون سلول مادر ظاهر میشوند.

رنگ آمیزی شفر فولتون چیست؟
روش رنگآمیزی شفر فولتون (Schaeffer Fulton Stain) پرکاربردترین روش برای رنگ آمیزی آندوسپور است. این تکنیک برای اولین بار توسط آلیس بی شفر و مک دونالد فولتون در دهه 1930 توصیف شد. در این روش از رنگ سبز مالاکیت به عنوان لکه اصلی و سافرانین به عنوان ضد لکه استفاده میشود. هنگامی که یک اسمیر با حرارت ثابت با محلول آبی مالاکیت سبز (لکه اولیه) پر میشود و بخار میشود، گرما به لکه کمک میکند تا از طریق اسپور نفوذ کند. در این تکنیک، گرمایش به عنوان یک ماده مثر عمل میکند. هنگامی که اندوسپور لکه را جذب کرد، در برابر رنگ زدایی مقاوم است، اما سلولهای رویشی به راحتی با آب رنگ میشوند (سلولهای رویشی بی رنگ می مانند). هنگامی که با سافرانین رنگ آمیزی میشود، سلولهای رویشی رنگ سافرانین را به خود می گیرند و برعکس اندوسپورهایی که سبز به نظر میرسند قرمز یا صورتی به نظر میرسند.
هنگام دیدن زیر میکروسکوپ، سلولها باید دارای سه ویژگی باشند: سلولهای رویشی باید صورتی/قرمز (یعنی رنگ ضد لکه) ظاهر شوند، سلولهای رویشی حاوی اندوسپورها باید صورتی رنگ شوند در حالی که هاگها باید بصورت بیضی سبز در داخل سلولها دیده شوند. اندوسپورهای بالغ و آزاد نباید با باکتریهای رویشی همراه باشند و باید به صورت بیضی سبز دیده شوند. اسمیر موجودات زنده را برای آزمایش وجود اندوسپورها روی یک اسلاید میکروسکوپ تمیز آماده کرده و با هوا خشک کنید. اسمیر را با حرارت برطرف کنید. یک تکه کوچک کاغذ لکه دار (کاغذ جاذب) را روی اسمیر قرار دهید و اسلاید (سمت لکه را به سمت بالا) روی یک گاز سیمی روی پایه حلقه قرار دهید.
کاغذ لکه را با محلول لکه سبز مالاکیت و بخار به مدت 5 دقیقه اشباع کنید، کاغذ را مرطوب نگه دارید و در صورت نیاز رنگ بیشتری اضافه کنید. از طرف دیگر، اسلاید را میتوان روی ظرف آب جوش بخارپز کرد. وقتی کاغذ شروع به خشک شدن میکند یک یا دو قطره سبز مالاکیت اضافه کنید تا مرطوب بماند، اما آنقدر آن را در یک زمان اضافه نکنید تا دمای آن به میزان قابل توجهی کاهش یابد. بعد از 5 دقیقه اسلاید را با استفاده از گیره لباس از قفسه جدا کنید کاغذ لکه را بردارید و اجازه دهید اسلاید به مدت 2 دقیقه در دمای اتاق خنک شود. سرسره را با آب شیر کاملاً بشویید (برای شستن مالاکیت سبز از دو طرف اسلاید میکروسکوپ).
اسمیر را به مدت 2 دقیقه با سافرانین رنگ کنید. دو طرف اسلاید را بشویید تا لکه ثانویه از بین برود و اسلاید/ هوا خشک شود. باکتریها را در زیر بزرگنمایی کل 1000X (غوطهوری در روغن) مشاهده کنید. وقتی زیر 1000X میکروسکوپ نوری مشاهده میشود، سلولهای رویشی صورتی/قرمز و اسپورها سبز رنگ به نظر میرسند.
رنگ آمیزی کپک ها چگونه است؟
رنگ آمیزی لاکتوفنول پنبهای (LPCB) یک روش ساده رنگآمیزی بافت است که برای بررسی میکروسکوپی و شناسایی قارچها استفاده میشود. روش رنگآمیزی لاکتوفنول پنبه آبی (LPCB) بر اساس اصل کمک به شناسایی دیوارههای سلولی قارچ کار میکند. قارچها موجودات یوکاریوتی با ویژگیهای ماکروسکوپی و میکروسکوپی هستند. دیواره سلولی اسپور قارچی از کیتین تشکیل شده است که اجزای تشکیلدهنده محلول لاکتوفنول پنبه آبی برای شناسایی رنگآمیزی میشود. محلول لاکتوفنول آبی پنبه به عنوان محلول نصب کننده و همچنین عامل رنگآمیزی عمل میکند. محلول شفاف و آبی رنگ است و از ترکیبی از سه معرف اصلی تشکیل شده است:
- فنل: با از بین بردن موجودات زنده به عنوان ضد عفونی کننده عمل میکند.
- اسید لاکتیک: برای حفظ ساختار قارچی
- آبی پنبهای: برای رنگ آمیزی یا رنگآمیزی به کیتین روی دیواره سلولی قارچ و سایر ساختارهای قارچی
این رنگ ظاهر قارچها را به رنگ آبی از اسپورها و ساختارهای قارچ مانند هیفها نشان میدهد. محلول رنگ آمیزی پنبه لاکتوفنول 50 میلی لیتری شامل موارد زیر است:
- آب مقطر 50 میلیلیتر
- آبی پنبهای (آبی آنیلین) 0/125 گرم
- بلورهای فنل (C6H5O4) 50 گرم
- گلیسرول 100 میلیلیتر
- اسید لاکتیک (CH3CHOH COOH) 50 میلیلیتر
- اتانول 70 درصد
محلول لاکتوفنول پنبهای آبی به مدت بیش از دو روز آماده میشود و واکنشگرها را دست نخورده میگذارند تا حل شود و به بلوغ برسد.
- روز 1: آبی پنبهای را در آب مقطر حل کرده و بگذارید یک شب استراحت کند. این رنگ نامحلول را از بین میبرد.
- روز دوم: با استفاده از دستکشهای محافظ، بلورهای فنل را به اسید لاکتیک در یک لیوان شیشهای اضافه کنید و با همزن مغناطیسی هم بزنید تا کریستالها حل شوند.
- گلیسرول را اضافه کنید آبی پنبهای و آب مقطر را درون محلول فنل + گلیسرول + لاکتیک اسید فیلتر کرده و مخلوط کنید.
- در دمای اتاق نگهداری شود.

روش انجام رنگآمیزی به ترتیب زیر است:
- روی یک اسلاید شیشهای میکروسکوپی تمیز، یک قطره 70 درصد اتانول اضافه کنید.
- بسته به نمونه استفاده، نمونه قارچ را با استفاده از یک دستگاه استریل مانند حلقه تلقیح (از محیط جامد) به قطره الکل اضافه کنید.
- نمونه قارچ الکل را با استفاده از دستگاه سوزن خراش دهید تا مطمئن شوید که نمونه به خوبی با الکل مخلوط شده است.
- با استفاده از قطره چکان یا پیپت، قبل از خشک شدن اتانول، یک یا دو قطره محلول لاکتوفنول پنبه آبی را اضافه کنید.
- بدون ایجاد حباب هوا روی لکه، لکه را با یک روکش تمیز و استریل با دقت بپوشانید.
- برای بررسی وجود اسپورهای قارچی و سایر ساختارهای قارچی، لکه را به صورت میکروسکوپی در 40X بررسی کنید.
در نهایت اسپورهای قارچی، هیفها و ساختارهای میوهای آبی رنگ و پس زمینه آبی کم رنگ میشود. مثلا:
- Aspergillus niger هیفها و ساختارهای بارده را به رنگ آبی ظریف با زمینه آبی کم رنگ رنگآمیزی میکند.
- Trichophyton mentagrophytes هیفها و ساختارهای بارده را نیز به رنگ آبی ظریف با زمینه آبی کم رنگ رنگآمیزی میکند.
این روش رنگآمیزی محدودیتهایی دارد که عبارتند از موارد زیر:
- فقط میتوان از آن به عنوان یک روش شناسایی احتمالی قارچها استفاده کرد که باید با سایر ابزارهای تشخیصی مانند معاینه بیوشیمیایی و محیط کشتی پیگیری شود.
- اجزای محلول باید قبل از انقضا استفاده شود از جمله استفاده از محلول قبل از انقضای آن.
- این محلول ممکن است مورفولوژی اصلی قارچها را مختل کند.
- این رنگآمیزی فقط برای شناسایی قارچهای بالغ و ساختارهای آن قابل استفاده است و نه شکلهای رویشی جوان قارچها.
- رنگ را نمیتوان برای مدت طولانی ذخیره کرد.
آزمایشگاه میکروبیولوژی بالینی
معاینه میکروسکوپی اولین آزمایش تشخیصی در پردازش نمونهها در آزمایشگاه میکروبیولوژی بالینی است. گزارش به موقع نتیجه لکه گرم، اطلاعات مهمی در مورد وجود و علت عفونت به پزشک میدهد. رنگ آمیزی طیف وسیعی از رنگآمیزی دارد و باکتریها را به صورت گرم مثبت یا گرم منفی طبقه بندی میکند. با وجود اهمیت بالینی لکه گرم، استانداردهای کمی برای خواندن و تفسیر این آزمون وجود دارد. اختصاص مقادیر نیمه کمی و کمی به تعداد سلولها و باکتریهای مشاهده شده به وضوح دلخواه است، زیرا معیارهای منتشر شده برای استفاده عمومی به طور چشمگیری متفاوت است.
اگرچه آزمایشگاهها ممکن است فقط معیارهای نیمه کمی رنگ آمیزی گرام را گزارش دهند، داشتن یک طرح استاندارد برای تخصیص مقادیر سلولها و باکتریها به نمرات نیمه کمی فردی مهم است. از آنجا که چندین مطالعه بالینی نشان داده است که وجود مقادیر متوسط تا سنگین چرک یا وجود باکتری روی لکههای گرم با وجود عفونت ارتباط دارد، اطلاعات گزارش شده از لکههای گرم نمونهها باید دقیق باشد.
امنیت در آزمایشگاه میکروبیولوژی
میکروبیولوژی علمی است که به بررسی زیستشناسی موجودات میکروسکوپی میپردازد. اگرچه تک تک سلولهای این موجودات ممکن است مستقیماً با میکروسکوپ مشاهده شوند و شکل و فعالیت آنها مشاهده شود، اما برای بررسی سایر ویژگیها مانند متابولیسم یا ژنتیک، رشد سلولها در جمعیتها (به نام محیط کشت) روش ارجح است. برای بسیاری از انواع آزمایشات، همه سلولهای جمعیت باید اساساً یکسان باشند. چنین جمعیتهایی محیط کشت خالص نامیده میشوند.
مجموعه ای از تکنیکها که بیشتر در اواخر قرن نوزدهم توسط رابرت کخ، لویی پاستور و همکاران آنها توسعه یافت، امکان جداسازی باکتریها از محیط طبیعی آنها و جداسازی آنها را در محیط کشتهای خالص برای مطالعه بیشتر فراهم آورد. احتمالاً بیش از هر چیز دیگری، اینها تکنیکهایی هستند که میکروبیولوژی را به عنوان یک زمینه مطالعاتی علمی تعریف میکنند. تخمین زده شده است که کمتر از 1 درصد باکتریها را میتوان در آزمایشگاه کشت داد.
میکروبیولوژیستها با تأمین غذا، آب و سایر نیازهای رشد، باکتریها را در محیطی با دمای رشد ثابت و راحت پرورش میدهند. این الزامات بسته به شرایط رشد طبیعی برای جمعیت میکروبی مورد مطالعه متفاوت است. غذا در محیط کشت مورد استفاده ارائه میشود و ممکن است به شکل مایع (به نام آبگوشت)، جامد یا نیمه جامد، در لولهها یا در ظروف کشت (پتری دیش) باشند.

برای اطمینان از اینکه فقط باکتریهای خاصی را که می خواهیم کشت میشوند و هیچ چیز دیگری از محیط درون محیط کشت نیست، مجموعهای از تکنیکهای آسپتیک در آزمایشگاه میکروبیولوژی انجام میشوند که از آزمایشکننده در برابر باکتریهای موجود در محیط محافظت میکنند و همچنین از محیط کشت در برابر آلودگیهای محیطی محافظت میکنند.
- همه باکتریها پاتوژنهای بالقوه هستند که ممکن است در شرایط غیر منتظره یا غیر معمول باعث آسیب شوند. اگر شما به عنوان یک دانشآموز دارای نقص سیستم ایمنی یا بیماری اخیر هستید، باید شرایط خود را با کارشناس آزمایشگاه در میان بگذارید.
- بدانید که تجهیزات ایمنی خاصی در آزمایشگاه مانند کپسول آتش نشانی و ایستگاه شستشوی چشم قرار دارد.
- نماد بینالمللی خطرات زیستی در آزمایشگاه میکروبیولوژی را به رسمیت بشناسید و بدانید که کجا و چگونه همه مواد زائد، به ویژه زباله های زیستی را دفع کنید. توجه داشته باشید که تمام زبالههای زیستی باید قبل از ورود به جریان زباله توسط اتوکلاو استریل شوند.
- همه چیز غیر از محیط کشتها و ابزارهای مورد نیاز خود را روی بنچ آزمایشگاه خاموش کنید.
- تمام تجهیزات و ملزومات مورد استفاده مربوط به کشت باکتریایی در آزمایشگاه میکروبیولوژی باید استریل شوند. این شامل رسانههایی است که استفاده میکنید و همچنین ابزارهای مورد استفاده برای انتقال محیط کشت یا باکتریها، مانند ابزار تلقیح (حلقه و سوزن) و پیپتها برای انتقال مایع.
- انتقال محیط کشتهای مایع توسط پیپت، هرگز نباید با مکش دهان انجام شود.
-
محیط انجام آزمایشات را قبل و بعد از کار با محیط کشت ضدعفونی کنید.
- در صورت نشت تصادفی با کشت باکتریایی، محل نشت را کاملاً با مواد ضدعفونی کننده اشباع کنید، سپس با حولههای کاغذی بپوشانید و اجازه دهید نشت به مدت 10 دقیقه بماند. سپس حولههای کاغذی اشباع شده را با دقت بردارید، آنها را در سطل زبالههای خطرناک بیاندازید و دوباره محل را با مواد ضد عفونیکننده تمیز کنید.
- هنگام کار با محیط کشتها دستکش بپوشید و پس از اتمام کار دستکشها را در زبالههای زیست محیطی دور بریزید.
- استفاده از عینک ایمنی توصیه میشود.
- قبل از خروج از آزمایشگاه میکروبیولوژی مطمئن شوید که بنچها کاملاً تمیز شدهاند و همه چیز دور ریخته یا به محل ذخیرهسازی برگردانده شده است.












